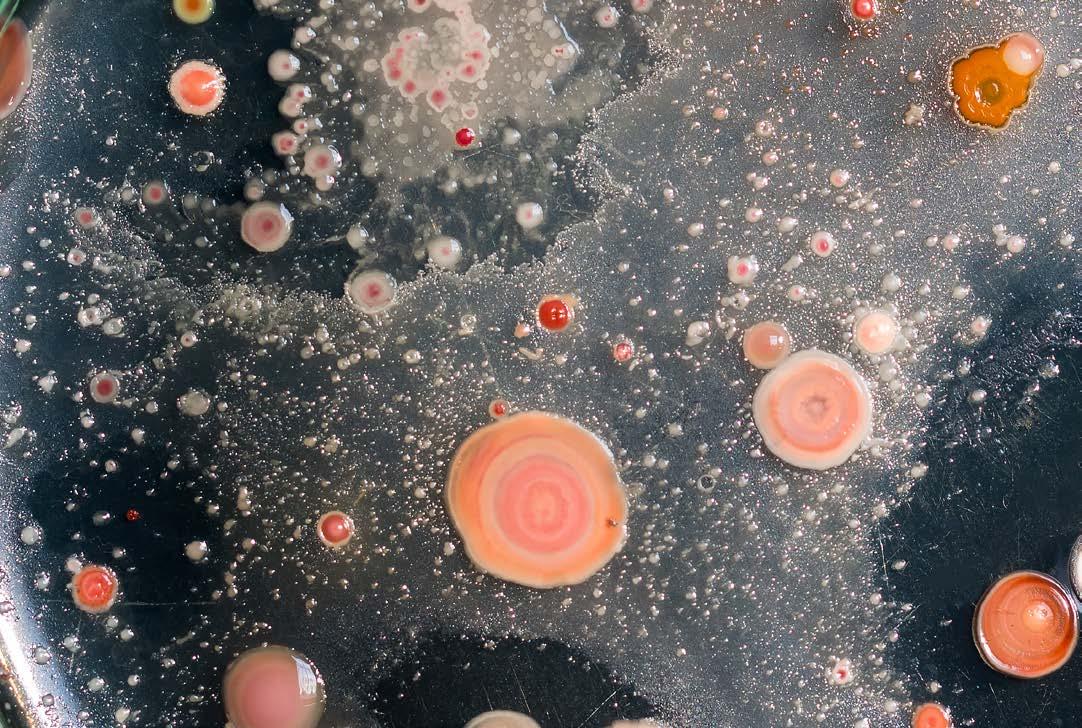

![]()


Meine Klasse macht gutes Klima.
So wie die Stadt Wiener Wäldchen für ein besseres Klima pflanzt, engagiert sich auch Barbaras Klasse in Währing für die Biodiversität vor ihrer Schule.
Mach auch du mit! Und melde dich zum Klima-Campus Newsletter an. Hier findest du Veranstaltungen, Tipps und Workshops rund um das Thema Biodiversität.
Die Umweltzerstörung und das Klima, sein Kippen und all die daraus resultierenden anderen Katastrophen, die wir uns mehr oder weniger konkret vorstellen können, spielen sich draußen ab. Wenn wir die nötigen Veränderungen, die unser Draußen wiederherstellen, nicht hinkriegen, werden wir uns auch drinnen nicht vor den Folgen verstecken können, schon klar. Aber ein Zuhause, in dem man sich wohlfühlt und erholt, ist Voraussetzung für fast alles. Nur: Die Probleme von draußen kriechen in unsere Häuser und Wohnungen, sie ziehen bei den offenen Fenstern herein, schleichen sich in Paketlieferungen mit Pfannenwendern und Backformen in unsere Küchen, treiben durch unsere Wasserhähne, durchdringen die Blut-Hirn-Schranke und dürfen dort dann gut einwirken: Feinstaub, Nanoplastik, Pfas (Per- und polyfluorierte Alkylsubstanzen) können den Erholungsfaktor schon recht deutlich schmälern. Und das tun sie auch. Großteils, ohne dass wir es merken. Doch ob Formaldehyd, das aus Möbeln aus Spanplatten steigt, Nanoplastik, das aus Polyestersofas auffliegt, Schimmelsporen, die aus Lüftungsschächten an wasserfeste Wandfarbe geblasen werden, oder die nach wie vor gern ignorierte enorme Feinstaubbelastung durch Hausbrand und hier den Klassiker Holzheizung: Mit vielem davon können wir vergleichsweise einfach aufhören. Die Alternativen sorgen dann auch draußen für die dringend nötige Entspannung der Lage. Mehr dazu auf den kommenden Seiten, gute Lektüre wünscht, eure BIORAMA-Redaktion

Irina Zelewitz, Chefredakteurin zelewitz@biorama.eu
IMPRESSUM
HERAUSGEBER Thomas Weber CHEFREDAKTEURIN Irina Zelewitz AUTORiNNEN Marianne Falck, Theresa Girardi, Martin Mühl, Ursel Nendzig, Thomas Weber GESTALTUNG Stefan Staller ANZEIGENVERKAUF Herwig Bauer, Michael Mazelle, Thomas Weber DRUCK Walstead NP Druck GmbH, Gutenbergstraße 12, 3100 St. Pölten PRODUKTION & MEDIENINHABERIN Biorama GmbH, Windmühlgasse 9/14, 1060 Wien GESCHÄFTSFÜHRUNG Martin Mühl KONTAKT Biorama GmbH, Windmühlgasse 9/14, 1060 Wien; www.biorama.eu, redaktion@biorama.eu BANKVERBINDUNG Biorama GmbH, Bank Austria, IBAN AT44 12000 10005177968, BIC BKAUATWW ABONNEMENT biorama.eu/abo ERSCHEINUNGSWEISE BIORAMA 6 Ausgaben pro Jahr ERSCHEINUNGSORT Wien.
BLATTLINIE BIORAMA ist ein unabhängiges, kritisches Magazin, das sich einem nachhaltigen Lebensstil verschreibt. Die Reportagen, Interviews, Essays und Kolumnen sind in Deutschland, Österreich und der ganzen Welt angesiedelt. Sie zeigen Möglichkeiten für ein Leben mit Qualität für den Menschen und den Planeten Erde. Ohne dabei den Zeigefinger zu erheben. BIORAMA erscheint sechs Mal im Jahr. Zusätzlich erscheinen wechselnde BIORAMA-Line-Extentions.
PEFC-zertifiziert
Dieses Produkt stammt aus nachhaltig bewirtschafteten Wäldern und kontrollierten Quellen www.pefc.at
PEFC/06-39-08

So machen sich biobasierte Baumaterialien in der Praxis: ihr Beitrag für ein gesundes Raumklima und gegen den Klimawandel.
03 Editorial
06 Bild der Ausgabe
08 Street Talk
10 Global Village
14 Biobasierte Baumaterialien. Ihr Beitrag fürs Raumklima und gegen den Klimawandel.
22 The more the merrier! Mikrobiomforscherin Gabriele Berg im Interview.
25 Von A wie Apfel bis Z wie Zimt. Die 30-Pflanzen-Woche im Familienalltagstest – und ihr wissenschaftliches Fundament.
28 Wie ein Gruß aus dem Herbstwald:
Die Haselnuss direkt vom Hof oder als süße Creme aus dem Glas.
38 Kochbuchempfehlung »Huhn mit Knochen« aus Samin Nosrats »Etwas Gutes«.
43 Geschenketipps der Redaktion
46 Rezensionen Empfehlungen, Warnungen.
49 Aus dem Verlag
MARKTPLATZ
34 Marktplatz Food Sanddorn x 6
KOLUMNEN
50 Elternalltag

Ob direkt vom Hof oder als süße Creme aus dem Glas: Die Haselnuss schmeckt wie ein Gruß aus dem Herbstwald. Geschichte einer Wiederentdeckung.





Schenken ist schwierig – jedes Jahr aufs Neue. Wir versuchen es trotzdem.

Drei Säfte, drei Aufstriche mit geballtem Geschmack.

Diese Pistaziencreme verführt mit fein-nussigem Aroma, die samtige Textur zergeht auf der Zunge. Mit Liebe und Sorgfalt im Allgäu hergestellt – aus besten Zutaten aus nachhaltiger Landwirtschaft. Da erzählt jeder Löffel eine kleine Geschichte von Qualität und Hingabe.
Wir machen Bio aus Liebe seit 1974.

Das Mehrfamilienhaus »Valley Widnau« des Beratungs- und Planungsunternehmens Openly steht seit Sommer 2024 im Schweizer Kanton St. Gallen, in Widnau (das der Rhein vom österreichischen Lustenau trennt). Sein Bauherr und Gründer von Openly, Andy Keel, hat hier, vor allem zu Demonstrationszwecken, ein Gebäude errichtet, das ohne Offsetting CO2-neutral gebaut wurde und als zertifizierte Kohlenstoffsenke (samt handelbaren CO2-Zertifikaten) wirkt. Möglich wurde das durch den Einsatz von Reuse-Stahlträgern und Recycling-Stahl, Zwischendecken und Innenwänden aus Lehm und einer Außenkonstruktion aus Holzrahmen, Hanfkalk und Hanfziegeln. Das gesamte System ist modular konzipiert – sowohl die Komponenten klimaschonender Bauweise als auch die Bauteile im Gebäude sind grundsätzlich variabel: So können etwa auch die Innen- und Trennwände der derzeit 19 Wohnungen neuen Nutzungsbedürfnissen während der geplanten Mindestnutzungszeit von 100 Jahren angepasst werden.
openly.systems



43, Angestellte
Die regionalen Produkte, die ich einkaufe, und dass ich meinen Kindern dort vermitteln kann, wie viel man aus diesen Produkten selber machen kann. Außerdem auch mein Balkonkraftwerk – und die Art, wie ich mein Zuhause erreiche: Wir haben bei der Wohnungssuche darauf geachtet, dass es eine gute Anbindung an den öffentlichen Verkehr und ans Radwegenetz gibt – nun brauchen wir das Auto nur mehr, um zu den Großeltern aufs Land zu kommen.

39, selbstständiger Tontechniker
Dass ich Müll trenne zum Beispiel. Ich finde es absurd, dass es Menschen gibt, die das Zurückbringen von Dosen als Zumutung empfinden, obwohl zumindest in Wien alle paar Hundert Meter eine Rückgabemöglichkeit besteht. Auch den recycelbaren Müll nehme ich einfach täglich zum nächsten Container mit, wenn ich aus dem Haus geh.

76, Rentner
Die Küche. Wir kaufen saisonal ein – und so wird es auch verarbeitet – einkochen, einwecken, einfrieren … Wir wohnen allerdings in einem alten Haus, das wird mit Öl beheizt, zusätzlich wenn nötig mit Holz. In unserem Alter passt das aber auch so, wir werden das nicht mehr ändern.

68, Architekt
Es ist kompakt! Ein durchschnittlich gut isolierter Wiener Altbau, ich verbrauche wenig Platz und wenig Energie – die Energiequelle allerdings ist eine Gastherme, dafür gibt es leider noch keine gute Lösung.

35, Architekt
Ich bin gerade aus der Uni raus und umgezogen, dabei hab ich auf Nachhaltigkeit ehrlich gesagt nicht sonderlich Wert gelegt, aber mein Vermieter schon: Der verzichtet nämlich bei seiner Altbauwohnung, die ich über einen Freund vermittelt bekommen habe, auf eine Mieterhöhung, weil er darauf vertraut, dass er in mir einen langfristigen Mieter gefunden hat. Ich achte bei der Einrichtung auf Nachhaltigkeit, ich habe alte Bauernmöbel, muss nichts neu kaufen. Was das Wohnen noch nachhaltiger machen würde: wenn meine Freundin und ich zusammenziehen und aus zwei Wohnungen eine machen würden.

62, Stimmbildnerin
Zum Beispiel mein Lebensmittelvorrat – ich versuche, immer Bioprodukte zu kaufen und einmal in der Woche mache ich das auf dem Wochenmarkt. Ich koche ausschließlich selbst, kaufe keine Konservendosen oder Fertigprodukte. Ich wohne in einem kleinen alten Haus und lege alle meine Wege zu Fuß oder mit meinem Fahrrad zurück.

55, selbstständiger Berater
Erstens die Lage, weil ich überallhin zu Fuß gehen kann. Zweitens die Fernwärme. Drittens der Strom, denn da kann ich viel beim Verbrauch sparen. Zusätzlich hat auch die Stadt Wien in puncto Verkehrspolitik einen Beitrag geleistet – einige Parkplätze vor dem Haus wurden aufgelöst und diese Fläche steht jetzt für anderes zur Verfügung.

36, Ernährungstherapeutin Ich koche dort viel erstens selbst und zweitens aus regionalen Zutaten. Sie befindet sich in einem Neubau, der ist zwar gut isoliert, aber leider heize ich mit einer Gastherme, das ist also nicht nachhaltig. Das für mich Wichtigste ist aber ein minimalistischer Lebensstil: Wir wohnen zu dritt auf 70 Quadratmetern, da kann man gar nicht zu viel anhäufen – auch Lebensmittel nicht groß lagern und dann verdirbt auch weniger. Ich achte darauf, fast alles von der Kleidung über Möbel bis hin zu Kinderspielsachen über Plattformen für Gebrauchtwaren wie Willhaben zu beziehen und wieder dort zu verkaufen, wenn es nicht mehr gebraucht wird.









WIESELBURG:
Derzeit ist durch Klimawandel und »Eschentriebsterben« heimisches Eschenholz in Hülle und Fülle verfügbar.

Das biegsame und besonders zähe Holz der Esche war historisch in der Wagnerei und im Fahrzeugbau bedeutsam. Hochwertige Werkzeugstiele sind auch heute noch meist aus Esche. Lange wurde der mächtige Laubbaum auch für Möbel, Furniere, Böden und zum Drechseln verwendet. Vor allem der Hype um Eichenholz, der mittlerweile bereits mehrere Jahrzehnte andauert, hat die Esche zuletzt aus mitteleuropäischen Wohnräumen verdrängt. Auch die Autokorrektur des Textprogramms möchte aus Eschenholz beharrlich Eichenholz machen. Zu Unrecht, wie Wolfgang Sunk, Geschäftsführer des auf Laubholz spezialisierten Sägewerks und Holzverarbeiters Wibeba aus Wieselburg (Niederösterreich), meint: »Die Esche ist ein stark unter Wert geschlagenes Holz«, sagt er und bedauert: »Wir haben es gerade in Hülle und Fülle verfügbar – auch durch den Klimawandel –, in Europa aber keinen funktionierenden Eschenholzmarkt. Wir exportieren deshalb 95 Prozent des österreichischen Eschenholzes nach Asien.« Vor allem Pilzbefall, das sogenannte »Eschentriebsterben«, führt dazu, dass mehr Eschenholz am Markt ist als sonst. Im Baumarkt muss man es mittlerweile aber manchmal extra bestellen. Dabei wäre es ein Gebot der Nachhaltigkeit, dieses Holz auch regional zu nutzen. Genaue Zahlen zum Escheneinschlag sind weder in Deutschland noch in Österreich verfügbar. In Deutschland bedeckt die Esche (laut Bundeswaldinventur 2022) immerhin noch 1,8 Prozent der Waldfläche (Kiefer: 21,8 %, Fichte: 20,9 %, Buche: 16,6 %, Eiche: 11,5 %). THOMAS WEBER
wibeba-holz.com

WIEN GROSSFELDSIEDLUNG:
Die Wiener Bäder der 1980er-Jahre bekommen ein preisgekröntes Holz-Update.








Die 2024 fertiggestellte Trainingsschwimmhalle Großfeldsiedlung (Wien Floridsdorf) wurde gemäß »Wiener Bäderstrategie 2030« saniert und um ein neues Bad erweitert. Das Sanierungskonzept sollte – so der Auftraggeber Stadt Wien – als Modell auch für weitere Sanierungen baugleicher anderer Bäder aus den 1980er-Jahren dienen. Nun hat auch die Jury des im September zum vierten Mal vergebenen Holzbaupreises Wienwood zum Hallenprototyp von Architektur Arge Illiz befunden: »Diese Art der Transformation von bestehenden Schwimmbädern in Holzbauweise kann in der Stadt Wien weiter Schule machen«. Er zeichne sich vor allem durch das Holztragwerk aus Brettschichtholzstützen, weitspannenden Brettschichtholzträgern und einem Dach aus Brettsperrholz der 6 Meter hohen neuen Schwimmhalle aus. Derzeit wird nach selbem Plan die Sanierung des Bades in Simmering umgesetzt.












Ziel des Holzbaupreises, der Proholz Austria – einer Interessengemeinschaft der österreichischen Holzwirtschaft – in Kooperation mit der Stadt Wien vergeben wird, ist es, »das Bewusstsein für die vielfältigen gestalterischen Möglichkeiten, das technologische Potenzial und die ökologischen Qualitäten des Baustoffs Holz zu stärken.« Ausgezeichnet wurden neben der Trainingsschwimmhalle Großfeldsiedlung auch der mehrgeschossige Wohnbau »Woody – M«, die Rudolf-Steiner-Schule Wien-Mauer sowie das Kleingartenhaus »Villa Minimale«.
illiz.eu proholz.at/wienwood
IRINA ZELEWITZ




















Damit bei dir alles läuft:
1 × täglich das Immunsystem + kicken und ShotSocken holen.





Jetzt zum Kauf von 4 Flaschen!*

































+ 1 Shot (95 ml) deckt den Tagesbedarf eines Erwachsenen. Vitamin C trägt zu einer normalen Funktion des Immunsystems bei. Eine abwechslungsreiche, ausgewogene Ernährung und eine gesunde Lebensweise sind wichtig für dein Wohlbefinden.
*4 Shot Flaschen kaufen, Bon(s) auf voelkel.bio/shotsocken hochladen und 1 Paar Voelkel Shot-Socken erhalten. Solange Vorrat reicht. Teilnahmebedingungen online.


HARD:
Die Pet-Weinflasche ist zurück und wiegt 330 Gramm weniger als die Einwegglasflasche.
»Fast so robust wie Diamant« – das Vorarlberger Produktionsund Recyclingunternehmen von Kunststoffverpackungen Alpla (ehemals »Alpenplastik Lehner Alwin OHG«) beweist in der Beschreibung seiner neuen, explizit für Wein entwickelten Flasche aus Polyethylenterephthalat (kurz PET), Humor. Dabei liegen die Vorteile von Kunststoff auf der Hand: Eine 50 Gramm leichte und bruchsichere Weinflasche findet zweifellos ihr Publikum. Verfügbar in den Größen 0,75 Liter und 1 Liter, in Weiß und Grün und mit unterschiedlich hohem Recycling-Pet-Anteil. Sie sind mit den auf den Glasflaschen eingesetzten herkömmlichen Metall-Drehverschlüssen kompatibel und somit auch mit den Abfülllinien der Weinhersteller. Ob der Glasflasche insgesamt ernsthaft Konkurrenz gemacht werden kann? Gelernten ÖsterreicherInnen ist zumindest der lange im PET-Gebinde erhältliche Doppelliter noch in Erinnerung – und auch der saisonal erhältliche (leicht kohlensäurehaltige) Sturm findet sich in Supermärkten nur in Plastikflaschen. Nun ist es der Weinhersteller Wegenstein, der als Entwicklungspartner der Pet-Weinflaschen fungiert hat und diese nun einführt – erhältlich sind sie derzeit in den österreichischen Rewe-Märkten (Penny, Billa und Billa Plus). Der CO2-Fußabdruck ist im Beispiel der Wegenstein-Weinflasche bei gleicher Füllmenge um 171 g CO2 – oder 38 % – niedriger als der der zuvor genutzten Einweg-Glasflasche. Allerdings setzt sich der ökologische Fußabdruck bekanntlich nicht nur aus den freigesetzten Treibhausgasen zusammen.
IRINA ZELEWITZ alpla.com

KLOSTERNEUBURG:
Die Einführung einer Mehrwegflasche beim Wein könnte viel CO2 einsparen.
Verschiedene Studien, wie eine des Österreichischen Umweltbundesamts und des Bundesamts für Wein- & Obstbau, zeigen, dass die Einwegglasflasche für rund die Hälfte der CO 2 -Emissionen im Betrieb eines Weinguts verantwortlich ist. In Österreich sind Mehrwegflaschen bei Bier oder bei Mineralwasser ein Erfolgsmodell und zeigen, dass es auch geht. Beim Wein konnte man sich bisher auf kein System einigen. Nun gibt es eine neue nationale Initiative, gestartet von der Einrichtung »Höhere Bundeslehranstalt (HBLA) und Bundesamt für Wein- und Obstbau« in Klosterneuburg, dem Österreichischen Ökologie-Institut, dem Wiener Beratungsunternehmen Circular Analytics, der Lagerhaus-Dachorganisation Raiffeisen Ware Austria und dem Gastrofachhändler Biogast. Die neue Mehrweg-Weinflasche wurde für mindestens zwölf Umläufe entwickelt. Bei einer Füllung pro Saison hält die Flasche über ein Jahrzehnt. In der ersten Phase ab März 2026 gibt es die Weine in Mehrwegflaschen bei den WinzerInnen direkt, im Wein- bzw. Bio-Fachhandel oder in der nachhaltigen Gastronomie. Die weitere Verbreitung im Lebensmitteleinzelhandel macht dieser laut der Initiative von der Nachfrage der KonsumentInnen abhängig. WinzerInnen, die darauf vertrauen, dass ihr Wein zählt, und die auch bei der Verpackung nachhaltig agieren wollen, können die Flaschen und dazugehörigen Kisten in Kürze vorbestellen.
mehrwegweinflasche.at
MARTIN MÜHL

Unser Matcha-Pulver ist ideal für eine kleine Pause.� Du brauchst einen MatchaChasen (Besen) und etwas Zeit.

So machen sich biobasierte Baumaterialien in der Praxis:
ihr Beitrag für ein gesundes Raumklima und gegen den Klimawandel.

Beispiel für nachhaltiges Bauen: Das Bürogebäude von Clarissakork im Bregenzerwald aus Holz, Hanf und Kork.

Gute Geschichten beginnen oft mit einer Wendung eines persönlichen Schicksals: Als sich Werner Schönthaler bei einem Sportunfall die Wirbelsäule bricht, liegt er mehrere Wochen lang im Spital. Dort fällt ihm auf, wie sehr die Luft im Krankenzimmer steht. »Man konnte gar nicht gesund werden.« 15 Jahre lang konzentriert sich Schönthaler fortan auf die Entwicklung eines neuen, ökologischen Baustoffs, der gut fürs Raumklima ist und nach seiner Verwendung restlos recycelt werden kann. Der Südtiroler wird fündig im Hanf – einem Material, das schon vor Jahrtausenden verarbeitet worden ist.
Heute machen Hanfziegel einen großen Teil des jährlichen Umsatzes des Familienunternehmens Schönthaler Baustoffe aus. Sie werden in Einfamilienhäusern, Firmenzentralen und öffentlichen Kindergärten verbaut. Für Schönthaler liegt der größte Vorteil des Materials in seiner einfachen Verarbeitung: »Eine Schicht von nur 38 Zentimetern reicht aus, um ein Haus perfekt für Sommer und Winter zu dämmen. Es kann richtig kalt werden, man braucht nichts draufkleben. Wird das Gebäude einmal abgerissen, können die Steine aus Hanf-Kalk ohne Probleme wiederverwendet werden. Es entsteht kein Abfall.«
Herkömmliche Wandaufbauten bestehen zumeist aus vielen Schichten, Plastikabdichtungen und synthetischen Klebern. All das entfällt bei Hanfbauten. Die Ziegel werden aufeinandergeschichtet und mit Kalkmörtel verklebt. Es wird ein Putz aus Lehm oder Kalk aufgebracht: fertig ist die Wand. Wie gut sich die Mischung aus Naturmaterialien aufs Wohnklima auswirkt, kann Schönthaler von seinem eigenen Heim berichten. Der alte Hof wurde während der Materialentwicklungen kurzerhand zum Reallabor. »Man spürt den Unterschied sofort. Daheim schlafe ich besser als in jedem Hotel.«
Hanf-Kalk-Steine speichern und reflektieren Wärme, sie regulieren Feuchtigkeit und

Wo gebaggert wird, fällt Lehm an: Hier eine Baustelle der Wiener Linien. Meist bleibt der wertvolle Baustoff jedoch ungenutzt – und wird auf die Deponie geführt.
sind in der Lage, Schadstoffe zu absorbieren. Diese angenehmen Eigenschaften sind messbar. »Hygroskopische, biobasierte Materialien wie Schafwolle oder Zellulosefasern puffern Feuchtigkeitsspitzen nachweislich. Wir quantifizieren dies über den sogenannten Moisture Buffering Value«, erklärt Universitätsprofessorin Azra Korjenic vom Forschungsbereich für ökologische Bautechnologien an der Technischen Universität (TU) Wien. Am Freiluftprüfstand experimentiert ihr Team mit Dämmungen aus nachwachsenden Rohstoffen. »Die Materialien dämpfen Tag- und Nacht-Schwankungen der Luftfeuchte und stabilisieren so das
Mikroklima in Räumen. Naturputze wie Lehm wirken außerdem reinigend und können Gerüche neutralisieren«, so Korjenic.
Oft sind natürliche biologische Dämmstoffe den gängigen Produkten aus Mineralwolle oder Styropor gar überlegen: »Unsere Untersuchungen zeigen, dass manche ökologische Dämmstoffe in Zusammenhang mit Holzrahmenbauweise fehlertoleranter sind als dichte, konventionelle Dämmungen, da sie Feuchtigkeit aufnehmen und diese nur begrenzt an die Holzkonstruktionen weitergeben.« Besonders Zellulose, Schafwolle und Stroh hätten sich auch unter extremen Bedingungen als robust erwiesen, sagt Korjenic. Hanf besitzt einen hohen Zellulose-Anteil. Die Ziegel, die Schönthaler vertreibt, werden mit sogenannten Schäben – dem hölzernen Teil des Stängels – hergestellt. Dieser Reststoff des landwirtschaftlichen Anbaus ist seit dem Comeback des Hanfs als Nahrungsmittel und für die industrielle Verarbeitung zu Textilien oder Kosmetika wieder reichlich vorhanden. Er gehört zu den schnell wachsenden, einjährigen Pflanzen und wird somit jedes Jahr vom Feld geholt.
Das hilft der Ökobilanz: Nach Berechnungen der EN15804, der Norm für die Erstellung von Umweltdeklarationen für Bauprodukte, wird in Hanfstein rund 90 Prozent mehr CO 2 eingespeichert, als im gesamten Zyklus von Anbau, Produktion und Wiederverwertung freigesetzt wird. »Anstatt Möglichkeiten zu suchen, Koh-
lendioxid in die Erde zu pumpen, sollten wir mehr Hanf-Häuser bauen«, sagt Schönthaler scherzhaft.
Der europäische Gebäudesektor hat sich ohnehin vorgeschrieben, bis 2050 klimaneutral zu werden. Neubauten sollen schon ab 2030 emissionsfrei sein. Ökologische Baustoffe bieten dafür einen doppelten Hebel, ist Bauingenieurin Korjenic überzeugt: »Sie senken im gesamten Lebenszyklus den CO2-Fußabdruck und verbessern dank ihrer feuchtigkeitspuffernden Eigenschaften das bauphysikalische Verhalten.« Doch sie werden noch immer selten eingesetzt. Laut einer Erhebung der Fachagentur für nachwachsende Rohstoffe haben biobasierte Dämmstoffe in Deutschland einen Marktanteil von nur neun Prozent. Es dominieren fossile und mineralische Produkte.
Für Sandra Böhm, wissenschaftliche Mitarbeiterin an der Professur für Nachhaltiges Bauen am Karlsruher Institut für Technologie, ist klar: »Die Zukunft des Bauens besteht aus zwei Bereichen: der urbanen Mine und der Natur.« Gemeint ist die Wiederverwertung von schon einmal verbauten, wiedergewonnenen Materialien und die Verwendung natürlicher, nachwachsender Rohstoffe. »Das heißt nicht, dass wir in Zukunft nicht mehr mit Beton bauen werden. Wir müssen uns aber gut überlegen: Wo ist Beton nötig? Wo finden wir Alternativen?« Bau- und Abbruchabfälle von Gebäuden machen 2023 unglaubliche 52 Prozent des Abfalls in Deutschland aus. Die Hälfte allen deutschen Mülls stammt also von Bauten, deren Bestandteile nicht mehr genutzt werden. Das muss sich ändern, findet Böhm. Biobasierte Baumaterialien seien klar im Vorteil, denn sie entstehen mit weniger Energie aus sich erneuernden Primärrohstoffen und können meist leichter wieder in ihre Einzelteile zerlegt werden. »Das Gute ist, dass diese Materialien oft als biologische Reststoffe oder Nebenprodukte in der Landwirtschaft und der Lebensmittelerzeugung anfallen«, sagt Böhm. »Sie müssen nicht eigens angebaut werden.«
HOLZ WIRD KNAPP, STROH GIBT’S GENUG
Zwar hat sich Holz als natürlicher Baustoff etabliert. Weltweit verbrauchen wir aber mehr da-
»Die Materialien dämpfen Tagund Nacht-Schwankungen der Luftfeuchte und stabilisieren so das Mikroklima in Räumen. Naturputze wie Lehm wirken außerdem reinigend und können Gerüche neutralisieren«
— Azra Korjenic, TU Wien
von, als nachwachsen kann. Andere biologische Rohstoffe hätten großes Potenzial: etwa Stroh. Die Dimension von dem, was auf unseren Feldern übrig bleibt, ist eindrücklich: »Allein das Stroh, das in Deutschland anfällt, würde ausreichen, um heute 350.000 Einfamilienhäuser zu dämmen«, so Böhm. Was für den Bodenerhalt auf den Feldern verbleiben muss und als Tiereinstreu gebraucht wird, sei bereits abgezogen.
Kein Baustoff war für Familie Steinmaßl naheliegender. 2021 haben Michael und Evi begonnen, ihr Strohhaus im bayerischen Kirchanschöring zu errichten. Das Ehepaar betreibt eine Bio-Landwirtschaft und hatte selbst Stroh von Dinkel- und Roggenpflanzen übrig. Was zusätzlich für die 70 mal 120 mal 150 cm großen Jumboballen nötig war, lieferte ein befreundeter Demeter-Bauer ums Eck. Nach nur neun Monaten Bauzeit zog die Familie ein. »Wir haben unser Haus wirklich vom Feld weg gebaut«, sagt Michael Steinmaßl und ist stolz darauf.
Gekostet hat das Strohhaus kaum mehr als ein konventioneller Holzbau. Dabei bietet es langfristig wirtschaftliche Vorteile: Die Strohballen isolieren so gut, dass nur geringe Betriebskosten anfallen. »Im ersten Winter lief die Heizung im Erdgeschoss nicht. Wir haben erst im März entdeckt, dass die Regler zugedreht waren. Es war aber immer schön warm.«
Ganz ohne statische Konstruktionshilfen kommen Baustoffe wie Hanf und Stroh allerdings noch nicht aus. In der Regel werden sie in Holzständerkonstruktionen eingebracht, um schwere Lasten auszuhalten. Für die Fundamente wird häufig auf Beton zurückgegriffen. Denn: Die Naturbaustoffe müssen vor dem feuchten

Azra Korjenic leitet den Forschungsbereich für ökologische Bautechnologien an der Technischen Universität Wien und beschäftigt sich unter anderem mit dem Nutzen biologischer Baustoffe für das Mikroklima in Innenräumen.
Link zum Planungstool von »natuREbuilt« der Technischen Universität Wien: naturebuilt.at/planungstool

Johannes Gutmann, SONNENTOR Gründer

Täglich verschwinden in Österreich über 11 Hektar Boden unter Asphalt und Beton. Was dabei verloren geht? Nicht nur Platz!
Versiegelter Boden atmet nicht, speichert kein Wasser – und wird zur langfristigen Bodenleiche!
Doch es geht auch anders: In Zwettl haben wir ein altes Stadt-Haus belebt, der Baukern stammt aus dem 13./14. Jahrhundert, statt neue Flächen zu verbauen. Die Stadt-Lofts sind unser Beitrag zu einem sanften, nachhaltigen Tourismus mitten in der Stadt.
Statt Abriss: behutsame Sanierung. Statt Neubau: Altbestand erhalten. Statt Wegwerfen: Upcycling mit Geschichte und Herz. Einige Stücke wurden uns geschenkt – andere haben wir aus abgerissenen Häusern gerettet, darunter Ziegel, Holz oder alte Fenster. Für uns ist das gelebtes Urban-Mining nach dem Motto: verwenden statt verschwenden. Alte Möbel, zu Lampen umgebaute Töpfe oder Körbe erzählen von früher – und geben dem Ort einzigartigen Charakter. Im Innenhof blüht heute ein Garten. Möglich wurde dieses Projekt nur durch regionales Handwerk, Liebe zum Detail und echte Überzeugung: Die eigene Region lässt sich aktiv mitgestalten. Die Stadt-Lofts sind mehr als Ferienwohnungen. Sie sind ein Zeichen: für kluge Raumnutzung, für Kreislaufdenken, für Zukunft mit Geschichten der Menschen, die dort gelebt haben.
www.sonnentor.com/stadt-loft
Biobasierte Baumaterialien haben eine wesentlich bessere Ökobilanz als fossile oder mineralische Baustoffe. So emittiert ein Mauerwerksbau etwa 53 Tonnen CO2-Äquivalente mehr als ein Stroh-Holzbau. Umgelegt auf die Reichweite eines Mittelklasse-Verbrenner-Pkw, kann ein Stroh-Holzbau hergestellt, betrieben und entsorgt werden und die BauherrInnen können zusätzlich elfmal um die Erde fahren, bis das Treibhauspotenzial eines Massivbaus erreicht ist.
Besonders aussagekräftig ist die Gegenüberstellung von Außenwänden: So speichert eine strohgedämmte Außenwand mit einem U-Wert von 0,15 W/(m²∙K) 46 kg CO2-Äquivalente pro Quadratmeter. Eine Porenziegelwand mit Zementputz hingegen emittiert 94 kg CO2-Äquivalente pro Quadratmeter. Noch schlimmer ist ein zweischaliges Mauerwerk: Es emittiert 131 kg CO2-Äquivalente auf den Quadratmeter. (Quelle: Leitfaden Strohbau 2024/ Fachagentur Nachwachsende Rohstoffe e. V.)
Untergrund geschützt werden. Michael und Evi Steinmaßl haben sich deshalb gegen den Bau eines Kellers entschieden. Und stattdessen für ein hinterlüftetes Holzstreifenfundament. Das Strohhaus sitzt also auf Fichtenbalken aus dem eigenen Wald der LandwirtInnen. »Man kann unter unserem Haus durchkrabbeln.«
Für die Umsetzung brauchte es ein gutes Stück Eigeninitiative. Zwar gibt es bereits Strohbaurichtlinien, die erklären, wie mit dem Baustoff umzugehen ist, über praktische Erfahrung verfügen allerdings noch wenige Baufirmen. »Unser Anspruch war, dass nichts verbaut wird, was kommenden Generationen zulasten fällt. Wir haben auf Styrodur, PUSchaum und alle möglichen weiteren, bedenklichen Baustoffe verzichtet«, sagt Michael Steinmaßl, »außer der Silikonfuge im Bad kann in unserem Strohballenhaus wirklich alles wiederverwendet werden«.
Dass das Gebäude CO2 speichert und somit dem Klima hilft, ist für die Bauleute ein schöner Nebeneffekt. Ein Quadratmeter Baustroh mit einem U-Wert von 0,15 W/(m²∙K) bindet 41 kg CO2-Äquivalente. Mineralische und synthetische Werkstoffe dagegen stoßen CO2-Äquivalente aus. Das ist so, weil das Getreide beim Wachsen Kohlendioxid aus der Atmosphäre zieht. Und die Herstellung der Strohballen wenig Energie benötigt: Bei der Ernte der Pflanzen wird das Stroh ohnehin gemäht, anschließend muss es nur noch getrocknet und zu Ballen verdichtet werden.
Und wie lebt es sich darin? Die Mär vom Strohhaus, das nichts aushält und beim leisesten Lüftchen davonweht, kann
Michael Steinmaßl nicht bestätigen. Aber: »Wer das Haus betritt, merkt, wie natürlich angenehm die Atmosphäre ist. Unsere Gäste sagen oft: ›Bei euch riacht’s so guat!‹« Der Wohnkomfort sei auch dem Innenputz aus Lehm geschuldet. Darin haben die Steinmaßls eine Wandheizung angebracht.
Dass ein gewachsener Baustoff mit einem mineralischen kombiniert wird, passiert heute immer öfter. Denn auch Lehm ist in Hülle und Fülle vorhanden. Bei praktisch jedem Bodenaushub werden Lehmschichten abgetragen und auf die Deponie geführt. Richtig wäre, dieses überschüssige Material an Ort und Stelle zu verbauen, ist Michaela Fodor überzeugt. Die Architektin engagiert sich bei den Young Earth Builders. Der in Wien ansässige Verein will Lehm als Baustoff wieder mehr Aufmerksamkeit verschaffen. Häufig würden angehende Architektinnen und Bauingenieure zwar im Studium darüber aufgeklärt, in der Praxis fehle es aber an Erfahrung, sagt Fodor. »Wir geben den Leuten die Möglichkeit, sich dreckig zu machen.«
Richtig aufbereitet, also mit Wasser angemischt, kann Lehm den Einsatz von gewach-
»Das heißt nicht, dass wir in Zukunft nicht mehr mit Beton bauen werden. Wir müssen uns aber gut überlegen: Wo ist Beton nötig?«
—
Sandra Böhm, Karlsruher Institut für Technologie
senen Baumaterialien wie Holz, Hanf, Stroh oder Bambus unterstützen. In ihrem Lager im dritten Gemeindebezirk zeigen die Young Earth Builders, wie man Lehmwürfel stampft und Lehmputze aufträgt. Zwar werde Lehm oft schon in Holzriegelbauweise als Dämmstoff angewandt, für massive Fertigteile sei sein Potenzial aber noch lange nicht ausgeschöpft, findet Fodor. Lehm habe ein Imageproblem. »Er gilt als weniger widerstandsfähig, weniger modern, weniger langlebig. Das kommt wahrscheinlich daher, dass Bauernhäuser früher meist mit Stroh und Lehm gebaut worden sind.


Sandra Böhm ist wissenschaftliche Mitarbeiterin an der Professur für Nachhaltiges Bauen am Karlsruher Institut für Technologie (KIT). In ihrer Doktorarbeit erforscht sie das Potenzial biogener Reststoffe in der Bauindustrie.



Michaela Fodor ist Architektin in Wien und engagiert sich bei den Young Earth Builders für ein Revival der Lehmbautechnik.
Doch nur weil das Material ein altes Material ist, ist es kein schwaches.«
Schon ein drei Zentimeter starker Lehminnenputz reicht, um die Luftfeuchte in Räumen zu regulieren und bei angenehmen 50 Prozent zu halten. Lehm kann durch seine offene Materialstruktur Wasserdampf von einem zum anderen Ort transportieren. Das beugt Schimmel vor und lässt Wände atmen. Außerdem besitzt Lehm die Eigenschaft, Wärme lange zu speichern und langsam wieder abzugeben. Damit können Gebäude mit starken Lehmwänden mit niedrigen Temperaturen beheizt und ohne großen Aufwand klimatisiert werden.
Wer Naturbaustoffe klug einsetzt, spart sich damit teure Gebäudetechnik. »In Deutschland gibt es bereits einen Gesetzesentwurf für
die Gebäudeklasse E. »E« steht für einfaches Bauen – dazu gehört auch der bewusste Einsatz weniger Materialien«, weiß Sandra Böhm vom Karlsruher Institut für Technologie (KIT). Laut Böhm müssen BauherrInnen nicht nur zu anderen Rohstoffen greifen, sondern auch die Konstruktionsmethoden überdenken. »Nur wenn wir kreislauffähige Fügetechniken nutzen, können natürliche Baumaterialien, nachdem sie in Gebäuden nicht mehr gebraucht werden, in einen neuen Lebenszyklus finden. Es wird möglichst nichts mehr verklebt, dafür gefaltet, gesteckt und verschraubt.«
Elementar ist dabei neben der Forschung die Vermittlung praktischen Knowhows. Die KIT-Materialbibliothek umfasst zahlreiche Naturbaustoffe, deren spezifische Eigenschaften in einer Datenbank öffentlich zugänglich sind. Auch an der TU Wien ist im Forschungsprojekt »natuREbuilt« unter Korjenic ein umfangreicher Bauteilkatalog entstanden, der Bau-
ende animieren soll, über biologische Alternativen nachzudenken. Er liefert praxistaugliche Detaillösungen, damit die Natur im Bauwesen keine Nische bleibt. Zuletzt kommt es – da sind die Materialforscherin und die Bauingenieurin einig – darauf an, auch junge Architekten und Handwerkerinnen für nachwachsende Baustoffe zu begeistern.
»Ein Gegengewicht zur fossilen Lobby« möchte schließlich auch Werner Schönthaler bilden. Die technische Zertifizierung seiner Hanfsteine in Deutschland hat drei Jahre gedauert und den Unternehmer viel Geld gekostet. »Für einen kleinen Betrieb ist der Weg zur Zulassung unglaublich schwierig.« Hohe Bauauflagen würden es neuen biobasierten Alternativen oft schwer machen, bestätigt Azra Korjenic. »Notwendig sind klare, lebenszyklusbasierte CO2-Zielwerte, vereinfachte Nachweiswege sowie öffentliche Beschaffung und die gezielte Ausbildung kommender Generationen als Markttreiber.«
Dabei eröffnet die Natur schier unendliche Möglichkeiten. Ein Karlsruher Unternehmen hat sich auf Neptungras spezialisiert. Es transportiert das abgestorbene und angeschwemmte Seegras vom Mittelmeer nach Deutschland, wo es als Dämmstoff verbaut wird. Ein anderes Naturmaterial, das gerade erst auf den Markt kommt, ist »NEWood« aus dem Wurzelgeflecht von Pilzen, das in den vergangenen Jahren als äußerst wandelbarer Rohstoff entdeckt wurde. Kolleginnen von Böhm haben »NEWood« am Karlsruher Institut für Technologie entwickelt und als Alternative zu herkömmlichen Spanplatten vorgestellt.
Böhm sagt dazu: »Pilzmyzelium ist in der Baustoffproduktion deshalb so interessant, weil es ortsunabhängig mit wenig Energie kultiviert werden kann.« Man brauche kein bestimmtes Klima, keine große Industrie und auch keine Landflächen. Lediglich: organische Reststoffe wie Kartoffelschalen oder Sägespäne als Substrat für die Pilzkulturen. Am Karlsruher Institut für Technologie wird der Pilzbaustoff im Labor herangezogen: »In zwei bis drei Wochen wächst ein Leichtbaustoff. Er erinnert an Styropor und wird in der Verpackungsindustrie schon eingesetzt.« Je länger man das Wur-
»Wird das Gebäude einmal abgerissen, können die Steine aus Hanf-Kalk ohne Probleme wiederverwendet werden. Es entsteht kein Abfall.«
—
Werner Schönthaler, Schönthaler Baustoffe
zelgeflecht wachsen lasse, umso dichter und robuster werde das Material, so Böhm. Bald könnte es auch als Dämmung zum Einsatz kommen. In verschiedenen Laboren wird derweil an massiven, tragenden Bauteilen aus Naturmaterialien jenseits von Holz geforscht. Eine Arbeitsgruppe der Technischen Hochschule Köln will Hanf die Eigenschaft verleihen, schwere Lasten zu tragen. An der Technischen Universität München werden Algen verwendet, um grünen Karbon herzustellen, der die Tragfähigkeit von Stahl aufweisen soll.
Erneuerbare Baustoffe werden immer breiter einsetzbar. Vielfach punkten sie heute schon, wenn es um die Sanierung von Gebäuden geht. Ein altes Mauerwerk kann mit einer dämmenden Innenwand aus Hanf-Kalk wieder fit gemacht werden. Lehm eignet sich, um Ziegeln einen frischen Putz zu verleihen und Schimmel vorzubeugen. So müssen in die Jahre gekommene Bauten nicht zwingend abgerissen werden. Naturbaustoffe sind eine günstige Alternative für alle, die Substanz erhalten wollen. Laut dem Hanfziegel-Hersteller Schönthaler würden viele Menschen in wirtschaftlich

Werner Schönthaler ist Baustoffhersteller in 2. Generation und hat Hanf-Kalk-Steine für die ökologische Dämmung von Gebäuden entwickelt.
Die Materialdatenbank des Karlsruher Instituts für Technologie: materialbibliothek.arch.kit.edu
Mehr zur Qualität von Pilzmyzel als Alternative zum giftigen Polystyrol, besser bekannt als »Styropor«
BIORAMA.EU/
GESUCHT-ERSATZ-FUER-EIN-MULTITALENT
schlechten Zeiten überlegen: »Was kann ich selber machen? Wo kann ich renovieren, statt neu zu bauen?« Hanf, Lehm und Stroh lassen sich nach einer fachkundigen Einführung relativ unkompliziert anwenden. Dafür ist kein Ingenieurstudium nötig, sagen Evi und Michael Steinmaßl aus Erfahrung. Hingegen: Mut, es anders zu machen.
INTERVIEW Martin Mühl
Mikrobiomforscherin Gabriele Berg über aktuelle Erkenntnisse zur Entwicklung und Förderung des Mikrobioms im menschlichen Darm.
Darm-Mikrobiom
Häufig auch Darmflora genannt, bezeichnet es die gesamte Gemeinschaft von Mikroorganismen, also Bakterien, Viren und Pilzen, die im menschlichen Darm leben und ein komplexes Ökosystem bilden.
Die Vielfalt des Darm-Mikrobioms ist ein wesentlicher Faktor und auch Indikator für dessen Gesundheit.
Ballaststoffe in der Ernährung fördern die Vermehrung nützlicher Darmbakterien – und sie ziehen sogar neue, vorteilhafte Bakterienarten an.
Die Biologin und Umweltbiotechnologin Gabriele Berg beforscht das Mikrobiom von Pflanzen, seine Wirkung auf Böden einerseits, aber auch auf die menschliche Gesundheit andererseits. Inzwischen ist dabei der Nachweis gelungen, dass biodynamisch produzierte Lebensmittel über ein vielfältigeres Mikrobiom verfügen, das auch zu größerer Diversität im menschlichen Mikrobiom beiträgt. Im Gespräch erklärt sie, welche Lehren wir daraus für unsere Ernährung, besonders die von Kindern, ziehen können
BIORAMA: Das Mikrobiom im Darm spielt lebenslang eine große Rolle für unsere Gesundheit. Wie entsteht seine
Zusammensetzung?
GABRIELE BERG: Ein Teil des Mikrobioms wird »vererbt«. Das bedeutet, es wird bei einer natürlichen Geburt auf das Baby übertragen. Auch die Muttermilch enthält wichtige Bakterien. Wir gehen jetzt davon aus, dass ungefähr die Hälfte der mikrobiellen Diversität von den Eltern und die andere Hälfte
vom Umweltmikrobiom stammt. Eine kritische Phase für das Darmmikrobiom beginnt mit der ersten Nahrungsaufnahme. Traditionell werden frische Früchte wie Blaubeeren, Äpfel und Bananen verabreicht, die auch eine Quelle für nützliche Darmbakterien sind. In den ersten Jahren entwickelt sich ein stabiles und ausgeglichenes Darmmikrobiom, das uns lange begleitet.
Ihre Forschung hat nun gezeigt, dass sich Lebensmittel aus biodynamischer Landwirtschaft hier als besonders günstig erweisen können. Hat dies etwa auch positive Wirkung im Zusammenhang mit der Entstehung von Allergien?
Früher Kontakt mit einem diversen Umweltmikrobiom hat sich als wichtiger Faktor gegen Allergien und Asthma erwiesen. Das trifft vor allem auf Kinder zu, die auf dem Bauernhof aufwachsen und viel Kontakt mit Tieren und Boden haben. Biodynamische Früchte und Gemüse zeichnen sich häufig durch eine hohe mikrobielle Diversität aus. Deshalb kann


Gabriele Berg
lehrt und forscht an der Technischen Universität Graz. Die Biologin und Umweltbiotechnologin wurde für ihre Arbeit im Bereich Pflanzenmikrobiom mit dem Wissenschaftspreis der Österreichischen Forschungsgemeinschaft (ÖFG) des Jahres 2025 ausgezeichnet.
»Eine kritische Phase für das Darmmikrobiom beginnt mit der ersten Nahrungsaufnahme.«
— Gabriele Berg
Umweltbiotechnologin
man davon ausgehen, dass sie auch gesund sind. Eine Studie ist mir dazu allerdings nicht bekannt.
Es ist daher besonders sinnvoll, gerade kleine Kinder mit regional gewachsenen Lebensmitteln zu ernähren und auf Exotik zu verzichten?
Frische, vielfältige und regionale Lebensmittel sind gesund und zu bevorzugen. Einmal etwas Exotisches auszuprobieren, ist sicher auch interessant. Allerdings haben diese Lebensmittel oft lange Transportwege hinter sich …
Was kann man in dieser Hinsicht als Erwachsener noch tun?
Man kann viel tun. Eine vielfältige und zumeist pflanzenbasierte Ernährung ist sehr gesund und erhält ein diverses Mikrobiom!



Pflegende Körperlotion in höchster Bio-Qualität mit rhythmisiertem Mistelextrakt aktiviert, harmonisiert und bildet eine schützende Hülle.
Kraftvoll und vitalisierend unterstützt Zitrone und Zirbelkiefer in allen Situationen, in denen Mut, Ausdauer und Widerstandskraft gebraucht werden.
Care Product gfaw.eu
Nature Care Product gfaw.eu
gfaw.eu
Nature Care Product gfaw.eu
Natural Cosmetics Standard gfaw.eu
gfaw.eu
gfaw.eu
Natural Cosmetics Standard gfaw.eu
Cosmetics Standard gfaw.eu Certified Sustainable Economics gfaw.eu
Certified
Care Product gfaw.eu
Nature Care Product gfaw.eu
Nature Care Product gfaw.eu
Nature Care Product gfaw.eu
Nature Care Product gfaw.eu
Nature Care Product gfaw.eu
Nature Care Product gfaw.eu
Nature Care Product gfaw.eu
Mehr Informationen zur Behandlung der Mistelextrakte im Fluidischen Oszillator und zur Qualität der Mistelprodukte unter www.sonett.eu/mistelform. Sonett GmbH, Mistelweg 1, 88693 Deggenhausen Erhältlich im Naturkostfachhandel.
Nature Care Product gfaw.eu
Nature Care Product gfaw.eu
Nature Care Product gfaw.eu
Nature Care Product gfaw.eu
Certified Sustainable Economics gfaw.eu
Vegan Society vegansociety.com
Certified Sustainable Economics gfaw.eu
Natural Cosmetics Standard gfaw.eu
Cosmetics Standard gfaw.eu
Label Vegan Society vegansociety.com
Economics gfaw.eu Label Vegan Society vegansociety.com
Label Vegan Society vegansociety.com
Natural Cosmetics Standard gfaw.eu
Natural Cosmetics Standard gfaw.eu
Natural Cosmetics Standard gfaw.eu
Natural Cosmetics Standard gfaw.eu
Natural Cosmetics Standard gfaw.eu
Natural Cosmetics Standard gfaw.eu
Sonett Klima-Engagement sonett.eu/klima-engagement
Klima-Engagement sonett.eu/klima-engagement
Klima-Engagement sonett.eu/klima-engagement
Certified Sustainable Economics gfaw.eu
Natural Cosmetics Standard gfaw.eu
Natural Cosmetics Standard gfaw.eu
Natural Cosmetics Standard gfaw.eu
Natural Cosmetics Standard gfaw.eu
Natural Cosmetics Standard gfaw.eu
Natural Cosmetics Standard gfaw.eu
Sonett Klima-Engagement sonett.eu/klima-engagement
Klima-Engagement sonett.eu/klima-engagement
Certified Sustainable Economics gfaw.eu
Certified Sustainable Economics gfaw.eu
Label Vegan Society vegansociety.com
Certified Sustainable Economics gfaw.eu
Certified Sustainable Economics gfaw.eu Label Vegan Society vegansociety.com
Certified Sustainable Economics gfaw.eu
Label Vegan Society vegansociety.com
Label Vegan Society vegansociety.com
Certified Sustainable Economics gfaw.eu
Label Vegan Society vegansociety.com
Certified Sustainable Economics gfaw.eu
Label Vegan Society vegansociety.com
Certified Sustainable Economics gfaw.eu
Label Vegan Society vegansociety.com
Label Vegan Society vegansociety.com
Certified Sustainable Economics gfaw.eu
Certified Sustainable Economics gfaw.eu
Label Vegan Society vegansociety.com
Certified Sustainable Economics gfaw.eu
Label Vegan Society vegansociety.com
Label Vegan Society vegansociety.com
Certified Sustainable Economics gfaw.eu
Label Vegan Society vegansociety.com
Label Vegan Society vegansociety.com
Label Vegan Society vegansociety.com
Certified Sustainable Economics gfaw.eu
Deutscher Nachhaltigkeitspreis 2022 Nature Care Product gfaw.eu
Economics gfaw.eu Label Vegan Society vegansociety.com
Deutscher Nachhaltigkeitspreis 2022
Deutscher Nachhaltigkeitspreis 2022
Deutscher Nachhaltigkeitspreis 2022
Deutscher Nachhaltigkeitspreis 2022
Deutscher Nachhaltigkeitspreis 2022
iF-communication design award
iF-communication design award
Sonett Klima-Engagement sonett.eu/klima-engagement
iF-communication design award
Sonett Klima-Engagement sonett.eu/klima-engagement
Sonett Klima-Engagement sonett.eu/klima-engagement
Sonett Klima-Engagement sonett.eu/klima-engagement
Sonett Klima-Engagement sonett.eu/klima-engagement
Sonett Klima-Engagement sonett.eu/klima-engagement
Deutscher Nachhaltigkeitspreis 2022 Nature Care Product gfaw.eu
iF-communication design award
Klima-Engagement sonett.eu/klima-engagement
reddot design award
Deutscher Nachhaltigkeitspreis 2022
Sonett Klima-Engagement sonett.eu/klima-engagement
Deutscher Nachhaltigkeitspreis 2022
Deutscher Nachhaltigkeitspreis 2022
reddot design award
Deutscher Nachhaltigkeitspreis 2022
Sonett Klima-Engagement sonett.eu/klima-engagement
reddot design award Sonett Klima-Engagement sonett.eu/klima-engagement
Sonett Klima-Engagement sonett.eu/klima-engagement
iF-communication design award reddot design award
www.sonett.eu
iF-communication design award
Sonett Klima-Engagement sonett.eu/klima-engagement
Deutscher Nachhaltigkeitspreis 2022
Deutscher Nachhaltigkeitspreis 2022
Sonett Klima-Engagement sonett.eu/klima-engagement
Sonett Klima-Engagement sonett.eu/klima-engagement
Deutscher Nachhaltigkeitspreis 2022
Sonett Klima-Engagement sonett.eu/klima-engagement
Deutscher Nachhaltigkeitspreis 2022
Deutscher Nachhaltig-
Deutscher Nachhaltig-
Deutscher Nachhaltigkeitspreis 2022
Deutscher Nachhaltig-
iF-communication
iF-communication
iF-communication
Deutscher Nachhaltigkeitspreis 2022
iF-communication design award reddot design
iF-communication design award
iF-communication design award reddot design
www.sonett.eu
iF-communication design award
iF-communication design award
www.sonett.eu
reddot design award
iF-communication design award reddot design award
iF-communication design award reddot design award Sonett Klima-Engagement sonett.eu/klima-engagement
reddot design award
reddot design award
iF-communication design award reddot design award
reddot design












Aber ein gesunder Bio-Boden kann viel mehr.
Er ist Lebensraum und Wasserspeicher in einem:






• Humusaufbau durch Gründüngung: Anbau von Pflanzen wie Leguminosen, die den Boden mit Nährstoffen versorgen und Bodenleben sowie Fruchtbarkeit fördern.
• Humusreicher Boden ist ein besserer Wasserspeicher: Schutz vor Dürre und Überschwemmungen.
• Verzicht auf chemisch-synthetische Spritz- und Düngemittel1 fördert Biodiversität.
• Nützlinge statt Pestizide 2 : So hält man Schädlinge auf natürliche Weise in Schach.
Gut für uns. Und die Natur natürlich.
1 gemäß EU-Bio-Verordnung
2 chemisch-synthetische Pflanzenschutzmittel
Gibt ,s nur bei:








Der Boden dankt es uns mit wertvollen BIO-Produkten.












Kann man mit 30 verschiedenen Pflanzen pro Woche den Darm fit halten und dabei im Familienalltag noch Spaß haben? Was die Wissenschaft zur 30-Pflanzen-Challenge sagt.
Awie Apfel. H wie Hanfsamen, Himbeeren und Hafer. T wie grüner Tee. W wie Walnuss. Z wie Zimt. Gemeinsam mit den Kindern zähle ich mich durch das Alphabet. Allein schon beim Frühstück komme ich auf 7 Pflanzen. S wie Soja(milch) gehört nicht dazu, denn sie ist hochverarbeitet.
Auch Säfte oder Marmeladen bringen keine Punkte. Marmelade besteht größtenteils aus Zucker, der Faser- und Nährstoffgehalt ist minimal. Gleiches gilt für Fruchtsäfte, da Fruchtfleisch und Schale entfernt werden. Beide tragen daher nicht wesentlich zur Darmgesundheit bei und entsprechen nicht dem Ziel der Challenge. Ist das Obst ganz und kommt so auf unseren Teller? Ist in dem Lebensmittel viel oder wenig Zucker? Schon die Kleinsten verstehen schnell, worauf es ankommt.
Die Herausforderung, 30 verschiedene Pflanzen pro Woche zu essen, mag für einige ambitioniert klingen. Das ist es aber gar nicht. Denn es geht eben nicht nur um Obst und Gemüse. Auch Olivenöl (im Gegensatz zu anderen Ölen), Nüsse, Kräuter und Hülsenfrüchte zählen dazu. Ob die Zutaten frisch oder tiefgekühlt sind, spielt dabei keine Rolle.
HERAUSFORDERUNG ANGENOMMEN!
Etwas später, nach dem Frühstück: K wie Kaffee. Macht 8, zähle ich innerlich. Ja, genau, so -
gar mein geliebter Kaffee liefert wertvolle pflanzliche Ballaststoffe. Für die Kinder würde sich – vielleicht zu einem späteren Zeitpunkt – K wie Kakao anbieten. Ihr Kind kennt bisher nur zuckersüßen Fertigkakao? Der bringt jedoch keine Punkte, handelt es sich doch um ein pappsüßes Fertiglebensmittel. Bieten Sie dafür reines Kakaopulver in Hafermilch an. Reines Kakaopulver liefert tolle Polyphenole und Ballaststoffe. (Die süßende Hafermilch bringt keinen weiteren Punkt.) Sie sehen schon: Die Challenge kann auch vielleicht eher skeptische Kinder dazu bringen, neue Lebensmittel zu probieren.
Es gibt verschiedene Ansätze, die Pflanzen zu zählen. Einige Challenges zählen Pflanzenpunkte und nicht Pflanzen. Dann werden Gewürze und Olivenöl nicht als 1 Punkt, sondern nur als je ein Viertel Punkt gewertet. Andere, wie die Autorin Katharina Seiser in ihrem Buch »30 Pflanzen pro Woche«, argumentieren, dass »ein halber Teelöffel Kurkumapulver oder Kreuzkümmel wesentlich mehr Futter fürs Mikrobiom liefern kann als eine ganze weitgereiste Glashausgurke« und empfehlen daher, in ganzen Pflanzen zu zählen. Auch, weil es einfacher ist.
B wie Blattsalat, M wie Mais, K wie Kidneybohnen, Knoblauch und Kreuzkümmel, O wie Olivenöl, P wie Paprikapulver, T wie Tomaten, W
TEXT Marianne Falck

»30 PFLANZEN PRO WOCHE – DAS KOCHBUCH
FÜR EIN LANGES
GESUNDES LEBEN:
REZEPTE, DIE DAS DARMMIKROBIOM STÄRKEN« Katharina Seiser, 2025, Brandstätter.
wie weiße Bohnen, Z wie Zwiebeln … mein Chili sin carne schmeckt lecker, unterdessen zähle ich die Punkte meines Mittagessens. Und schon 18 sind geschafft, nach nur einem halben Tag. Jede der Pflanzen wird dabei nur einmal pro Woche berücksichtigt. Verbrauche ich also Tofu und geröstete Edamame, zählt das nur einmal als »Soja«.
Warum aber sollen es wöchentlich 30 Pflanzen sein? Diese Anzahl wird derzeit als Minimum angesehen, damit die vielen verschiedenen Mikroorganismen gut im menschlichen Darm gedeihen können. Das ist eine zentrale Erkenntnis aus dem 2012 gegründeten »American Gut Project« (heute: The Microsetta Initiative) des renommierten Biologen Rob Knight und seines Teams von der University of California in San Diego (UCSD). Es untersuchte die Vielfalt der Darmmikroben. Mithilfe von Stuhlproben und Fragebögen zu Ernährung und Lebensstil wollten Forschende verstehen, wie Ernährung, Alltag und Gesundheit zusammenspielen. Dieses Citizen-Science-Projekt basiert auf Daten von über 11.000 TeilnehmerInnen. Bekannter wurde das Prinzip der 30 Plants a Week ab 2018 durch den britischen Epidemiologen Timothy Spector, der am Projekt beteiligt ist.
Die Vorgabe von mindestens 30 Pflanzen pro Woche ist ein Wegweiser für ein gutes Ernährungsmuster. Letztendlich sollte dies individuell nuanciert betrachtet werden. Jemand, der an einem Reizdarm, einer akuten Magen-Darm-Erkrankung, einem bestimmten Stoffwechseldefekt leidet oder mit einem aktiven Schub bei Morbus Crohn oder Colitis ulcerosa kämpft, muss zwangsläufig bestimmte Pflanzen meiden und kommt vermutlich schwerer auf die genannten Zahlen. M wie Mandeln und B wie Banane am Nachmittag. Schon 20 geschafft.
Lohnt es sich, einfach mal die Pflanzen auf seinem Teller zu zählen? Menschen, die wöchentlich mindestens 30 verschiedene pflanzliche Lebensmittel essen, haben eine deutlich größere Vielfalt im Darmmikrobiom als Personen mit weniger als zehn Pflanzen. Diese Vielfalt
fördert Bakterien, die kurzkettige Fettsäuren, »Short Chain Fatty Acids« (SCFA), produzieren. Butyrat, Propionat und Acetat sind die am häufigsten vorkommenden SCFAs im menschlichen Körper. Sie sind wichtig für eine gesunde Darmschleimhaut und entzündungshemmende Prozesse und sollen auch das Risiko für Darmkrebs verringern. Etliche Studien belegen, dass eine pflanzenbetonte Ernährungsweise zahlreiche Vorteile mit sich bringt, indem sie das Risiko für Herz-Kreislauf-Erkrankungen, Diabetes und frühzeitige Sterblichkeit verringern.
Wissenschaftler:innen weltweit beschäftigen sich zunehmend mit den Zusammenhängen zwischen Ernährung und dem individuellen Darm-Mikrobiom. Inzwischen ist klar, dass, wenn wir Pflanzen essen, wir auch Teile ihres Mikrobioms aufnehmen. Dieses unterscheidet sich stark, abhängig davon, wie der Apfel oder die Tomate produziert wurde – ob sie aus dem weit entfernten Gewächshaus oder aus dem eigenen Garten kommen, ob sie »gespritzt« wurden oder nicht.
Wer mit der Challenge starten will, aber nicht recht weiß, wie, schreibt am besten einmal einen Tag lang auf, welche Pflanzen den Weg auf den eigenen Teller finden. Und schaut dann, wo noch etwas draufgelegt werden könnte: mehr frische oder getrocknete Kräuter über das Essen streuen, etwas zusätzliche Rohkost zum Mittag oder ein paar Kerne oder Nüsse zwischendurch. Das bringt nicht nur mehr Farben auf den Tisch, sondern auch mehr Schwung in Ihr Mikrobiom. Das geht als Einzelne genauso gut wie in einer Gruppe. Pflanzen lassen sich gemeinsam mit Freunden oder der Familie zählen, so wird die Challenge zu einem Spiel. Welche Kombinationen schmecken am besten? Wie könnte man noch ein paar Punkte mehr erreichen?
Es ist einfacher, mehr Pflanzen einzubauen, wenn man weiß, dass es nicht um die Menge, sondern um die Variation geht. Dann streut man Hanf- und etwas Leinsamen auf das Erdnussbutter-Brot, heute Abend Schnittlauch über die Suppe und morgen dann vielleicht Petersilie? So bekommt man auch die Kleinsten dazu, vielleicht bisher verschmähte Kräuter oder Gemüsesorten zu probieren. Wir jedenfalls machen weiter.

Hergestellt werden die SPAR Natur*pur Bio-Eiskaffees von Ennstal Milch aus 100 % österreichischer Milch, die von regionalen Bio-Milchviehbetrieben wie jenen von Jungbäuerin Viktoria Gewessler kommt.
Seit 30 Jahren steht SPAR Natur*pur für höchste Bio-Qualität und langjährige Zusammenarbeit mit regionalen Betrieben.
Vor 30 Jahren setzte SPAR gemeinsam mit engagierten Partnern ein starkes Zeichen für Bio: Mit 10 Bio-Milchprodukten startete 1995 SPAR Natur*pur – eine Pionierleistung, die den Grundstein für die Erfolgsgeschichte der Bio-Marke legte. Die Philosophie: kurze Wege, transparente Herkunft sowie Frische und somit authentische Produkte mit Verantwortung. Heute umfasst das Sortiment rund 1.300 Artikel – entstanden aus jahrzehntelanger Zusammenarbeit auf Augenhöhe. Ennstal Milch, Kärtnermilch und MORGENTAU begleiten SPAR dabei seit den Anfangsjahren und stehen für Qualität, Innovation und regionale Wertschöpfung.
GEMEINSAM WACHSEN –INNOVATIONEN VON HEIMISCHEN BIO-BETRIEBEN
1995 war die Ennstal Milch aus Stainach-Pürgg mit der SPAR Natur*pur Bio-Bergbauern-Vollmilch Teil des ersten Sortiments von SPAR Natur*pur. Heute, 30 Jahre später, ist diese Milch nach wie vor erhältlich. Ein Produkt, das damit für Kon-
tinuität und Qualität steht. Mit dem laktosefreien SPAR Natur*pur Bio-Eiskaffee-Sortiment setzt die Molkerei auf Fortschritt. Auch die Kärntnermilch zählt zu den Vorreitern in der Bio-Produktion und ist Partner seit 1996. Durch Trendprodukte wie die neuen Bio-Skyr-Drinks zeigen sie ihre Innovationskraft. Beide Betriebe verzichten bereits in der Produktentwicklung auf zugesetzten Zucker in der Rezeptur – ein Beitrag zur Zuckerreduktionsoffensive von SPAR.
Den ersten Schritt in Richtung Bio-Gemüse machte SPAR gemeinsam mit MORGENTAU aus Hofkirchen im Traunkreis. Gründer Christian Stadler liefert seit den Anfangsjahren frisches Gemüse in bester Bio-Qualität und setzte neue Maßstäbe in biodynamischer Landwirtschaft. Der neue SPAR Natur*pur Bio-Suppenwürzer gibt Gemüse, welches nicht verkaufsfähig ist, eine zweite Chance.

Aus gerettetem Bio-Gemüse wird ein Glas voller Geschmack: Der SPAR Natur*pur Bio-Suppen-Würzer wird von MORGENTAU aus Hofkirchen im Traunkreis hergestellt.
Diese drei Betriebe stehen exemplarisch für langjährige Partnerschaften, die gemeinsam mit SPAR Bio in Österreich geprägt haben – mit Leidenschaft für Natur, Tierwohl und regionale Wertschöpfung.

Ob direkt vom Hof oder als süße Creme aus dem Glas: Die Haselnuss schmeckt wie ein Gruß aus dem Herbstwald.
Geschichte einer Wiederentdeckung.
Leise rieseln die Nüsse. Heftig und warm bläst der Wind. Und Christoph Böckl hofft, dass es jetzt im September oder Anfang Oktober nicht noch einmal richtig feucht wird. Nebel und Herbstnässe, wenn die Haselnüsse reif von den Sträuchern fallen, das wäre »furchtbar«, sagt der Biobauer. Dann sind die Nüsse schmutzig, schimmelgefährdet, lassen sich schlecht ernten. Alles schon erlebt, seitdem Böckl 2015 zweieinhalbtausend Haseln gesetzt hat. Neun Hektar, auf seinen besten Äckern, alle fünf Meter eine Pflanze; eingezäunt zum Schutz vor Reh und Feldhase; die Baumreihen weit genug auseinander, sodass er
bequem mit dem Traktor hindurchfahren, den Bewuchs kurz halten und rechtzeitig flämmen kann, um schließlich mit der Kehrmaschine die Nüsse einzusammeln. Der warme Wind ist gut. Er trocknet den Tau und entsorgt die Blätter. Das erleichtert auch seinen wichtigsten Mitarbeitern die Arbeit, von denen nur ein paar tiefe Löcher im staubigen Marchfelder Boden und breite Sitzstangen über der Umzäunung zeugen. »Die Füchse darf mir in der Gegend niemand anrühren«, sagt Böckl. Zwei Fuchsbauten gibt es in seiner Plantage. Auch über jeden Greifvogel freut sich der leidenschaftliche Jäger. Alle paar Zaunstangen hat er für sie eine
Sitzstange montiert. So können sie bestmöglich nach Feldmäusen (Nussdieben) und Wühlmäusen (Wurzelfressern) Ausschau halten.
2024 hatte er die erste nennenswerte Ernte seiner »Marchfeldnuss«. 800 Kilo Haselnüsse pro Hektar, »in der Schale«, relativiert er, »60 Prozent des Gewichts machen die Schalen aus«. Im Vollertrag sind seine Bäumchen noch lange nicht. »Ich bin ein alter Mann, bis das rennt«, sagt er, »das dauert ewig. Zum Glück habe ich die Haselnüsse ausgesetzt, bevor ich 40 war.« Bestenfalls werden die Bäume irgendwann 2500 Kilo pro Hektar abwerfen. Mittelfristig rechnet er mit 1500 bis 2000 Kilo. Ohne Schale sind das maximal 7200 Kilogramm im Jahresschnitt – vorausgesetzt, Wind und Wetter passen und Fuchs und Mäusebussard halten die Schädlinge in Schach.
GEFRAGT WIE NIE
Christoph Böckl hat viel in seine Haselplantage investiert. Auf 90 Prozent der von ihm bewirtschafteten Felder ist er immer noch ein klassischer Ackerbauer, baut Soja, Mais, Getreide an. Freude bereitet ihm aber vor allem die Haselnuss. »Ich würde am liebsten nur Haselnuss machen«, sagt er. Das liege vor allem an der Wertschätzung, die er mit der Nuss erfährt. »Die Haselnuss ist beliebt, du wirst als Bauer dafür geachtet und der Preis passt«, sagt er. »Wenn du Getreide anbaust, wirst du manchmal behandelt wie der letzte Dreck, da wird dir das Gefühl gegeben, dass du froh sein musst, dass dir das überhaupt jemand abnimmt.«
Das dürfte nicht nur im Marchfeld so sein, zumindest sind Haselnüsse weltweit gefragt wie nie. Ihre Hauptanbauregion ist die Schwarzmeerküste. Allein die Türkei, wo in manchen Jahren bis zu 75 Prozent der weltweiten Produktion passiert, hat ihre Anbaufläche von 440.000 Hektar (im Jahr 2010) auf mehr als 700.000 Hektar (2023) binnen weniger Jahre nahezu verdoppelt. Für 2025 rechnet das türkische Statistikamt –nach Nachtfrösten im April – mit einer schlechten Ernte von 520.000 Tonnen. Womit der Ertrag witterungsbedingt um ein Drittel zurückgegangen wäre. Italien produziert 85.000 Tonnen (2023), ebenso die USA. Für Deutschland und Österreich gibt es keine Ertragszahlen, nur Flächenangaben. In Deutschland werden auf 300 Hektar Haselnüsse kultiviert, in Österreich auf 220 Hektar (wovon 82 % biologisch bewirtschaftet werden). Damit lässt sich da wie dort nur ein Bruchteil des Bedarfs decken. »Deutschland ist mit Importen von über 69.000 Tonnen im Jahr 2023 weltweit einer der größten Abnehmer von Haselnüssen, wobei mehr als zwei Drittel aus der Türkei stammen«, heißt es in der »Kulturanleitung für den ökologischen Haselnussanbau in Deutschland«, einem 2024 erschienenen Leitfaden der Bayerischen Landesanstalt für Wein- und Gartenbau (LWG). Eine flächen-

Guten Tag, ich bin Fußgängerbeauftragte. Ich bewerbe das Zu-Fuß-Gehen und bemühe mich um schönere und sicherere Fußwege in Wien. Oft erzähle ich meinem Gegenüber, dass das Zu-Fuß-Gehen die Basis unserer Mobilität ist. Ohne Gehen kämen wir weder zum Fahrrad, noch zum Zug. Warum also nicht auch für das Zu-Fuß-Gehen bessere Bedingungen schaffen? Meist wendet sich das Gespräch nach einer Weile. Ich bekomme eine lange Wunschliste mit auf den Weg, wo
»Ich bewerbe das Zu-FußGehen und bemühe mich um schönere und sicherere Fußwege in Wien.«
— Petra Jens, Beauftragte für Fußverkehr der Stadt Wien
überall der Gehsteig breiter, die Ampel flotter und die Straße begrünter werden sollte. Wie gut, dass ich nicht allein bin! Auf dem ersten österreichischen Fußverkehrsgipfel in Graz trafen sich heuer hunderte meiner Profession. Sie alle haben ein Ziel: Mehr Raum schaffen für das Zu-Fuß-Gehen –in unseren Köpfen und auf unseren Straßen. mobilitaetsagentur.at
Ein Großteil der weltweiten Haselnussproduktion stammt von der Pontischen Hasel im Schwarzmeerraum.
Bereits der griechische Historiker Herodot (ca. 500 vor Christus) beschrieb die Haselnusskultur am Schwarzen Meer und die Verwendung von Haselnussöl.
deckende Selbstversorgung in Mitteleuropa anzustreben, wäre utopisch. Doch während Haselnussanbau früher vor allem der bäuerlichen Selbstversorgung diente und zwischenzeitlich weitgehend verschwunden war, erlebte der Haselnussanbau zuletzt eine Renaissance, insbesondere in den klimatisch günstigen Regionen Süddeutschlands und Österreichs. »Vor allem in den südlichen (deutschen, Anm.) Bundesländern wie Baden-Württemberg und Bayern entwickelte sich der Haselnussanbau in einzelnen kleinen Betrieben zu einem bedeutenden landwirtschaftlichen Erwerbszweig«, so der LWG-Leitfaden. In die Kulturanleitung flossen auch Ergebnisse eines 2017 abgeschlossenen elfjährigen Haselnussforschungsprojekts ein, das vom Bayerischen Ministerium für Ernährung, Landwirtschaft und Forsten gefördert worden war.
Haben sie genügend Licht (das Birkengewächs
gilt als besonders lichthungrig), dann wachsen wilde Haseln fast überall. Ertragreich kultivieren lassen sich Haselnussstauden aber nicht überall. Entscheidend ist es, die richtige Sorte für die Region zu finden. Weltweit stehen beinahe 500 Sorten zur Verfügung. Auch bedarf der Anbau der Haselnuss eines langen Atems und Experimentierfreude – weshalb einige erfolglose Bäuerinnen und Bauern ihre Plantagen auch wieder gerodet haben. Bereits 2005 setzte Helga Kindsmüller im bayerischen Obersüßbach erste Haseln aus. Die Pflanzen dafür – teils unbekannter Sorte – importierte sie damals aus Frankreich. »Mittlerweile wachsen auf 3,6 Hektar Haselnüsse mehrerer Sorten und 2024 haben wir erstmals richtig geerntet«, sagt die Naturland-Bäuerin. Mit 2,3 Tonnen Nüssen in der Schale von 1,8 Hektar ist sie zufrieden (»Der Rest der Flächen ist noch nicht im Ertrag.«). Herausfordernd bleibe das Kultivieren der Haselnuss aber – trotz des andauernden Austauschs mit den ObstbauexpertInnen der

Universität Weihenstephan. Viele Erfahrungen aus anderen Weltgegenden ließen sich nicht eins zu eins auf ihre Heimat umlegen, sagt sie: »Gerade beschäftigt uns, dass die nordeuropäischen Sorten so spät in die Reife kommen, dass wir sie bei schlechtem Herbstwetter nicht ernten können.« Nicht geklappt habe auch die Direktvermarktung, so Kindsmüller: »Ich habe das versucht. Die Resonanz war gleich null.« Über die Erzeugerorganisation Haselnuss wurde sie ihre Ernte trotzdem problemlos los. Die Nüsse seien sortiert, geknackt und geröstet in den Filialen großer Handelsketten gelandet, mehr weiß sie nicht. »Mittlerweile gibt es auch Anfragen von Leuten, die direkt kaufen wollen«, sagt sie, »aber ich kann nicht ein Jahr so machen und das andere so«.
Gelingt die Direktvermarktung, dann passt – wie bei Christoph Böckls »Marchfeldnuss« –nicht nur die Wertschätzung, sondern auch die Wertschöpfung. Der Biobauer, aus dessen Plantagen im Verkehrsdunst die Wiener Skyline zu sehen ist, verkauft seine Nüsse ausschließlich direkt: geknackt und geröstet als Öl oder – nicht biozertifiziert – als Rum. Er wolle nicht von Großen abhängig sein, sagt der Biobauer: »Ich habe keinerlei Werbung gemacht, weil ich anfangs eh zu wenig Ware hatte. Aber ich verkaufe den allergrößten Teil privat an die Durchschnittshausfrau, die zwei- bis dreimal vor Weihnachten backt.« In der warmen Jahreszeit bezieht ein Eisgeschäft aus der Gegend jede Woche ein paar Kilo Nüsse. Die Nachfrage, sagt Böckl, sei größer als seine Ernte.
Auch die Entwicklung hin zu stärker pflanzenbasierter Kost macht die Haselnuss immer gefragter. »VegetarierInnen sowie VeganerInnen sind immer mehr daran interessiert, ihren Eiweißbedarf nicht nur über Soja zu decken, sondern eben auch Nüsse dafür herzunehmen«, weiß Carola Nitsch vom Amt für Ernährung, Landwirtschaft und Forsten in Fürth, die von 2006 bis 2017 das bayerische Haselnussprojekt begleitete.
Der allergrößte Teil der globalen Haselnussernte wird freilich am Weltmarkt gehandelt. Kontrollierter Bioanbau mit strengen Auflagen bei Spritzmitteln, Gifteinsatz und Dün-


unreife Nüsse der Sorte »Runde Römer«.
gung ist bei den Großabnehmern bislang kein Thema. Allein der italienische Konzern Ferrero kauft für seine Markenprodukte (Nutella, Rocher, Duplo) bis zu 100.000 Tonnen Haselnüsse im Jahr. In manchen Jahren ist das bis zu ein Viertel der globalen Ernte. Genaue Zahlen zum Bioanteil der weltweiten Haselnussproduktion gibt es keine. Er wächst zwar, dürfte aber überschaubar sein. Zum Vergleich: Der deutsche Biopionier Rapunzel verarbeitet mittlerweile »je nach Jahr um die 1200 Tonnen Kerne, also nicht in der Schale«, sagt Barbara Altmann, die bei dem Unternehmen für Sustainable Supply Chain Management zuständig ist. »60 Prozent dieser Nüsse kommen aus unserem Haselnussprojekt in der Türkei, der Rest aus
Marchfeldnuss
Pionierbetrieb im Marchfeld (Niederösterreich), der seine Biohaselnüsse ausschließlich direkt vermarktet. marchfeldnuss.at
Rapunzel Welt
Erlebniswelt in Legau im Allgäu, indoor (mit großer Haselnuss-Kugelbahn) und outdoor (mit Haselnuss-Spielplatz). rapunzelwelt.de
»Deutschland
ist mit Importen von über 69.000 Tonnen im Jahr 2023 weltweit einer der größten Abnehmer von Haselnüssen, wobei mehr als zwei Drittel aus der Türkei stammen«
weiß Carola Nitsch, die für das Amt für Ernährung, Landwirtschaft und Forsten in Fürth von 2006 bis 2017 das bayerische Haselnussprojekt begleitete.


»DIE HASELNUSS –ARTEN, BOTANIK, GESCHICHTE, KULTUR« Jonas Frei, 2023, AT Verlag.
Umfassendes zur Corylus avellana vom Schweizer Landschaftsplaner und Stadtökologen Jonas Frei mit detaillierten Sorten- und Hybridbeschreibungen. Ein Prachtband.
Aserbaidschan und Italien.« Verarbeitet werden die Nüsse zwar in einer Vielzahl von Produkten. Das wichtigste davon ist allerdings die – untrennbar mit der Firmengeschichte und der Entwicklung der Biobewegung verbundene – Schoko-Nuss-Creme »Samba«. Damit schrieb Rapunzel ab 1990 Biogeschichte. Die damals noch überschaubare und kulinarisch eher karg und basic orientierte Biobranche kümmerte sich bis dahin vor allem um die Produktion von Grundnahrungsmitteln. Die Entwicklung eines zuckersüßen, aber ökologisch vertretbaren »Nutella-Ersatzes« in Bioqualität teilt die Geschichte der Biobranche in eine Zeit vor und eine Zeit nach »Samba«. Das Produkt symbolisiert die Abkehr der Ökobewegung von der Askese. Selbst picksüße Unvernunft und Bio sind kaum mehr für jemanden ein Widerspruch – im Gegenteil: Inwzischen steht Bio neben ökologischer Verantwortung vor allem für Genuss.
Mittlerweile gibt es die Kultcreme in mehreren Ausführungen und Verarbeitungen (von einer veganen Cremeversion in Dark oder Kokos bis zu Dinkelwaffeln, Schokokugeln bis zum Schnittensnack). Mit einer bereits 2009 entwickelten Weiterentwicklung – der veganen Creme »Bionella« – verdrängte Rapunzel Ende 2024 im 50. Jahr seiner Firmengeschichte sogar Nutella aus den Bordbistros und Restaurants der Deutschen Bahn. Das wichtigste Haselnuss- und Signature-Produkt von Rapunzel bleibt trotzdem die klassische »Samba«-Creme. »Mit 45 Prozent Haselnuss-Anteil hat keine an-
dere Schoko-Nuss-Creme am Markt einen höheren Haselnussanteil«, sagt Barbara Altmann, »da haut der Haselnusspreis gnadenlos rein«. Zum Vergleich: Bei Nutella (dessen Rezeptur in unterschiedlichen Weltgegenden variiert) beträgt er 13 Prozent. In Deutschland machen den größten Teil der Inhaltsstoffe Zucker und Fett (in Form von konventionellem Palmöl) aus. Auch in der Ende 2022 eröffneten »Rapunzel Welt« am Firmenstandort in Legau im Allgäu wird »Samba« entsprechend Raum gegeben. Eine der Attraktionen der Erlebniswelt: eine neun Meter lange Kugelbahn als interaktive Wandinstallation. Eine ganze Wand entlang lässt sich damit der Weg von Haselnüssen (Kugeln) vom Bioanbau an der türkischen Schwarzmeerküste bis ins Samba-Glas steuern und handfest nachvollziehen. Die Reise reicht von der händischen Haselnussernte am Strauch über die Trocknung und Sortierung, den Transport zur Knackanlage und den Transport nach Deutschland, wo im Labor die Qualitätskontrolle passiert, die Kerne geröstet, mit anderen Zutaten gemischt und gemahlen werden, bis zum Abfüllen, Verschließen und Etikettieren der Gläser. Auch den Außenbereich der Erlebniswelt prägt eine riesige Haselnuss aus Holz – als Klettergerüst und Teil der Rutsche am Spielplatz.
Weit genug zurückgedacht, lässt sich die ikonische Riesenhaselnuss sogar als Würdigung ihrer Verdienste um die Besiedelung Europas verstehen. Denn der etwa fünf Meter hohe Haselstrauch war »eines der ersten Gehölze, die dem Menschen nach den letzten Eiszeiten in Europa reichlich länger haltbare Nahrung bot«, schreibt der Schweizer Land -

Erlebniswelt von Rapunzel in Legau im Allgäu mit großer Haselnuss-Kugelbahn.
schaftsplaner und Stadtökologe Jonas Frei in seinem Haselnussbuch. Und »eine der wenigen Obstarten, die seit den Eiszeiten von sich aus in Europa heimisch wurde und heute noch kultiviert wird.« Denn die Pflanzen, auf denen Apfel, Marille/Aprikose, Weintraube, Walnuss oder Pflaume und Zwetschge wachsen, wurden alle aktiv vom Menschen eingeführt und verbreitet, die Walnuss sogar erst im Römischen Reich. Menschheitsgeschichtlich spricht man sogar von einer Hasel-Zeit. Von 8500 bis 7000 vor Christus prägte die Hasel als Pionierpflanze die nacheiszeitliche europäische Landschaft. Der Großstrauch bildete flächendeckend Gebüsche und niedrige Wälder. Die vermutlich in Hülle und Fülle verfügbaren Nüsse – eine fettreiche und gut lagerbare Winternahrung – waren eine wichtige Energiequelle für die mitteleuropäischen Clans des frühen mittelsteinzeitlichen Homo sapiens. Die Archäologin Daniela Holst prägte in ihren Arbeiten über die Funde am Duvenseer Moor (bei Hamburg) gar den Begriff der »Haselnussökonomie« als Basis der frühen Besiedelung Nordeuropas. AgrarhistorikerInnen vermuten sogar, dass die Hasel eine der ersten landwirtschaftlich genutzten Pflanzen gewesen sein könnte. Vor der schleichenden Sesshaftwerdung des Menschen und der Rückkehr der großen dominanten Schattenbaumarten in den Jahrtausenden nach der Eiszeit waren Haselnüsse jedenfalls ein wichtiges Sammelgut der JägerInnen und SammlerInnen. Gesammelt – beziehungsweise gestohlen – werden Nüsse auch heute noch. Christoph Böckl hat seine »Marchfeldnuss«-Plantagen deshalb seit einigen Jahren nicht nur eingezäunt, sondern auch abgesperrt und videoüberwacht. »Ich hätte es nicht für möglich gehalten, aber mir wurden immer wieder im großen Stil Nüsse gestohlen. Einmal waren über Nacht plötzlich zwei ganze Baumreihen völlig abgeerntet«, sagt der Biobauer. Besonders bitter, nachdem ein nennenswerter Ertrag der süßen Nüsse jahrelang auf sich warten hatte lassen. Seither hat Christoph Böckl seine Stauden von seinem Hof aus rund um die Uhr im Blick.

Supermarkt war gestern. Heute kommt das BioKistl zu dir.
Frischer, bunter, vielfältiger und in 100% Bio-Qualität. Direkt vom Feld, bequem zu dir nach Hause.
www.adamah.at
1

TEXT
Irina Zelewitz
BILD Stefan Staller
Säuerlich, leicht herb und etwas bitter, aber auch fruchtig-süßlich und ein kräftig orange strahlendes Fruchtfleisch: Was sonst fast nur die Zitrusfrüchte des Südens schaffen, kriegt der vor allem in Nordeuropa verbreitete Sanddorn geschmacklich hin – und mehr. Dieses Mehr an Geschmack bietet besondere kulinarische Möglichkeiten, ist aber eher dominant als subtile Begleitung. Das Mehr an wertvollen Nährstoffen – allen voran Vitamin C – sorgt dafür, dass nicht alle ihn wegen des etwas eigenwilligen Geschmacks zu schätzen wissen und dass er längst auch als Nahrungsergänzungsmittel in Form von Pulvern und Extrakten in Kapseln oder ohne gibt. Zuerst kann man es aber immer einmal mit Nahrung probieren. Es folgen daher sechs klassische Optionen zum Sanddornkonsum. Drei Mal zum Trinken, drei Mal zum Aufs-Brot-Streichen, zum Backen oder, um des Erhalts der vielen Vitamine willen: zum kalten Verfeinern von Desserts.
1
BIO SANDDORN, STAUD‘S
Mollig, süßlich, vanillig und mit Ananas-Noten macht Staud’s durch den Bio-Austria-zertifizierten Biosanddorn womöglich sogar seinen Marillen Konkurrenz – auf dem Brot oder, darauf könnte auch das »fein passiert« ein Hinweis sein, in feinem Gebäck und Weihnachtskeksen. stauds.com
2
3
2

SANDDORN ORANGE, ALNATURA
26 % Sanddornmark, aber mehr Orangensaft und Zucker. Trotzdem: Wer Sanddorn gerade wegen seines unverwechselbaren Geschmacks liebt, sollte ausgerechnet die Variante von Alnatura im Duett mit Orange versuchen. Guter Tipp vom Hersteller auch: Ab ins Salatdressing damit! alnatura.de
Tanja und Gabriel Kroisleitner von Sandicca kultivieren Österreichs ersten Biosanddorn auf 860
Metern Seehöhe im steirischen Joglland – und haben ihn von dort in diversen Varianten in den Handel von Apotheke bis Biomarkt gebracht. Tolle Sache, tolles Design, weniger Zucker wär angenehm. Außer: Man spritzt Dorn Quijote mit Soda statt mit Wasser –feine Alternative zu den einschlägigen Softdrinks ähnlicher Farbe.
sandicca.com
4
6
4 5
FRUCHTHELD SANDDORN, SONNENTOR
Durch die Fruchthelden-Brille von Sonnentor betrachtet, sind die Einsatzmöglichkeiten für Sanddorn in der Küche vielfältig – so auch die für diesen Aufstrich: Mit 60 % Biosanddornanteil und zurückhaltender Süße, die statt aus Zucker aus Apfelsaftkonzentrat stammt. Abgerundet durch Zitronensaftkonzentrat. sonnentor.com
5
SANDDORN
100 % MUTTERSAFT, VOELKEL
Purer Sanddornsaft ist nur was für die Harten. Die anderen verdünnen ihn – zum Beispiel 1:3 mit Wasser. Dafür eignet sich zum Beispiel der von Voelkel besonders gut, denn er stammt aus biodynamischem Anbau, ist aber nicht nur Demeter-, sondern auch Gemeinwohl-zertifiziert.
voelkel.bio
SANDDORN
6
100 % MUTTERSAFT, DM BIO
Noch einmal Saft. In einer etwas frischeren zitrus-sauren Variante präsentiert sich der Bio-Sanddornsaft mit Fruchtmark von Dm. Er enthält neben Sanddornsaft auch Sanddornmark, aber insgesamt nichts außer europäischem Biosanddorn. dm.at

OEndlich gibt es ein zweites Kochbuch der Autorin des großartigen »Salz. Fett. Säure. Hitze« (2018) – von Köchin und Kochlehrerin Samin Nosrat. Nach Netflix-Serie und Food-Kolumne in der New York Times hat Nosrat in »Etwas Gutes« alltagstaugliche Lieblingsrezepte und Wissenswertes über Zutaten, Küchenutensilien (auf einer Doppelseite sind alle abgebildet, die man
angeblich unbedingt braucht) und Kochtechniken aus ihrer Schatztruhe geholt – und daraus ein unprätentiöses, unkompliziertes Kompendium internationalen Soulfoods gemacht, bei dem einem schon bei der Lektüre wohlig wird. Das Gefühl bleibt beim Kochen erhalten, denn Nosrat findet den Königsweg zwischen ausreichender Erläuterung der durchzuführenden Schritte und straffen Texten. Zwi -

schen zweckdienlichen Hinweisen auf Zutatenentdeckungen, die jene mit Zugang zum gut sortierten internationalen Feinkosthandel und Muße, sich einzelne Zutaten um die halbe Welt schicken zu lassen, schwer ignorieren können – und Zutatenlisten, in denen gleich dabeisteht, womit man schwer zu bekommende oder umständlich selbst herzustellende Produkte substituieren kann. Ein praktischer Zugang, auf elaborierter Basis.
Kräutersauce, Salsa verde, Chimichurri, Zhoug, Chutney: Wie auch immer sie heißt, es geht nichts über eine gute grüne Sauce. Diese hier ist meine Abwandlung der legendären Version einer grünen Sauce vom Cheeseboard Collective in Berkeley, Kalifornien (manche alten Stammgäste kennen sie vielleicht noch als »Papi Chulo Sauce«).
Ein Hauch Senf hilft, dass diese cremige Koriandersauce beim Verarbeiten mit einem Stabmixer oder einer Küchenmaschine emulgiert. Verwende sie auf Pizza, Tacos, Reis und Nudelgerichten, zu gegrilltem oder gebratenem Fisch, Hähnchen oder Gemüse. Hebe ein wenig davon unter Krautsalat oder einen sommerlichen Salat mit gegrillten Zucchini und Mais. Oder rühre ein oder zwei Löffel in Whipped Tahin (siehe Seite 63), Joghurt oder Labneh ein, sie verleiht allem eine würzige, säuerliche Kräuternote.
ZUTATEN
ERGIBT 1 KLEINE SCHALE
• 4 Handvoll Koriander, grob gehackt
• 2 Knoblauchzehen, in Scheiben geschnitten
• 1 bis 2 Serrano-Chilis oder
• Eingelegte Thai-Chilis (Rezept im Buch),
• Stiele entfernt (optional)
• 1 EL Zucker
• 1 TL (3 g) koscheres Salz
• 125 ml natives Olivenöl extra
• 60 ml Chili-Essig (Rezept im Buch) oder gewürzter Reisessig
• 3 EL Zitronensaft, frisch gepresst
• 1 EL Dijonsenf
Koriander, Knoblauch und Chilis (falls verwendet) in die Küchenmaschine geben und mithilfe der Pulsfunktion fein zerkleinern. Zucker, Salz, Öl, Essig, Zitronensaft und Senf zugeben und pürieren, bis die Sauce eine einheitliche, cremige Konsistenz hat. Kosten und nach Geschmack mit Salz und Essig nachwürzen. Abdecken und im Kühlschrank bis zu einer Woche aufbewahren.

»ETWAS GUTES« von Samin Nosrat, 2025, Kunstmann.

ohne dabei an Cremigkeit einzubüßen. Wenn du auch nur ein bisschen so tickst wie ich, möchtest du diesen Dip an deinem Ende des Tisches bunkern.
ZUTATEN
ERGIBT 1 MITTELGROSSE SCHALE
• 60 ml natives Olivenöl extra, bei Bedarf mehr
• 2 gelbe Zwiebeln, in dünne Ringe geschnitten
• Koscheres Salz
• 2 EL helles Miso
• 1 EL Rotweinessig oder alter Sherryessig
• 375 g Labneh
• 1 1/2 TL Zwiebelpulver
• 3 EL Schnittlauch, fein gehackt, etwas mehr zum Garnieren
• Schwarzer Pfeffer, frisch gemahlen
• 1 TL Zucker (optional)
Zwiebeln dabei regelmäßig vom Pfannenboden abkratzen. Nach etwa 20 Minuten, sobald die Zwiebeln den Großteil ihrer Flüssigkeit abgegeben haben, legen sie sich vielleicht an einigen Stellen an und beginnen leicht anzubrennen. Bei Bedarf einen Schuss Wasser zugießen, um anhängende Zwiebelstücke zu lösen. Solange sie nicht angebrannt sind, abkratzen und wieder unterrühren. Sollte doch etwas angebrannt sein, kein Wasser zugeben, sondern den Pfanneninhalt, natürlich ohne die angebrannten Teile, in eine frische Pfanne umleeren, vielleicht mit einem zusätzlichen Löffel Öl. Ungefähr 45 bis 55 Minuten weiter anbraten und regelmäßig abkratzen, bis die Zwiebeln schön karamellisiert sind. Vom Herd nehmen und Miso sowie Essig unterrühren. Abschmecken und mit Salz und Essig nachwürzen. Die Zwiebeln abkühlen lassen, dann fein hacken. In einer
großen Schüssel mit Labneh, Zwiebelpulver, Schnittlauch und ein wenig frisch gemahlenem Pfeffer vermischen. Probieren und nach Geschmack nachsalzen, eventuell Zucker hinzufügen, um Salz und Essig auszubalancieren. In einer Schüssel anrichten und mit Schnittlauch garnieren. Mit Kartoffelchips, warmen Pita-Taschen, Crudités oder Crackern servieren. Reste halten sich im Kühlschrank abgedeckt bis zu einer Woche.
GESCHMORTES HUHN MIT APRIKOSEN UND HARISSA
Ich dachte, mit Harissa kenne ich mich aus, schließlich hatte ich es fast zwei Jahrzehnte lang selbst gemacht. Doch dann probierte ich einen Löffel der üppigen, weinroten Paste aus dem unbeschrifteten Glas, das die Brüder Mansour und Karim Arem mir auf meine Türschwelle gestellt hatten. Sie waren gerade dabei, Zwïta zu gründen, ein Unternehmen, das ihr tunesisches Erbe zelebriert. Während westliche Köchinnen und Food-Autoren mit der Küche des Nachbarlandes Marokko einigermaßen vertraut sind, waren wir bis jetzt recht ahnungslos, was Tunesien und seine kulinarische Geschichte angeht. Und vom Harissa der Arem-Brüder auf den Rest zu schließen, haben wir da wirklich etwas verpasst.
In die aus milden, sonnengetrockneten Chilis bestehende traditionelle tunesische Chilipaste wandern außerdem Knoblauch, Kümmel und Koriander. Diese geschmacklich vielschichtige und besonders dicke Paste ist eine Offenbarung für all jene, die Harissa bislang nur als Pulver oder aus der Tube kennen (oder in irgendeiner anderen Version, die aus Tomatenprodukten, hydriertem Chilipulver oder frischen Paprikaschoten zusammengeschustert wurde). Sobald ich dieses Harissa probiert hatte, setzte ich es bei meinem alltäglichen Kochen ein, ich rührte es in Knoblauch-Kräuter-Labneh (siehe vorne) und verteilte es über gebratenes Gemüse. Eine meiner liebsten Verwendungsmethoden ist es jedoch, das Harissa zum Einreiben oder als Marinade für Huhn zu verwenden. Als ich Mansour fragte, welche anderen Gewürze ich diesem Schmorgericht beigeben sollte, empfahl er mir Tabil, eine auf Koriander basierende Gewürzmischung, die jede tunesische Familie anders zubereitet. In manchen Haushalten besteht sie fast ausschließlich aus Koriandersamen! Er erzählte mir auch, dass Kreuzkümmel in Tunesien nur selten verwendet und stets erst gegen Ende der Kochzeit zugegeben wird, um das Gericht nicht zu erschlagen. Mit Mansours Ratschlägen im Kopf experimentierte ich mit den Gewürzen herum, um für dieses Rezept









































mein eigenes Tabil zu entwickeln. Jedes Mal, wenn ich das Gericht für Freundinnen und Freunde zubereitet habe, ist kein Krümel übrig geblieben. Da ich immer mildes Harissa verwende, schlecken selbst Kinder mit einer ausgeprägten Abneigung gegen Gewürze den köstlichen Bratensaft auf und knabbern ihre Hühnerkeulen bis zum Knochen ab. Das Rezept funktioniert einfach immer. Ich empfehle dir dringend, dieses Hühnergericht mit gedämpftem Couscous zu servieren, da er sich mit dem Bratensaft vollsaugt, den man auf diese Weise bis zum letzten Tropfen genießen kann.
ZUTATEN
Erfordert Marinieren über Nacht
Für das Tabil
• 2 EL Koriandersamen, gemahlen
• 1 1/2 TL Kurkuma
• 1/2 TL Kümmel,
• 8 Hühneroberschenkel,
• mit Haut und Knochen (ca. 1,4 kg)
• Koscheres Salz
• 2 EL milde Harissapaste
• 3 EL Kardamom-Ghee (Rezept im Buch), Ghee oder natives Olivenöl extra
• 1 gelbe Zwiebel, in dünne Ringe geschnitten
• 2 Karotten, geschält und im Rollschnitt (Erklärung im Buch)
• in ca. 2 cm große Stücke geschnitten
Zum Servieren
• Koriandergrün und zarte Stiele
• Gedämpfter Couscous,
• Farro (Perldinkel) oder Reis gemahlen
ZUBEREITUNG
• 1/2 TL frisch gemahlener schwarzer Pfeffer Für das Huhn
• 8 Knoblauchzehen im Ganzen, geschält
• 250 g fein gehackte Tomaten (aus der Dose oder frisch)
• 250 ml Hühnerfond (Rezept im Buch) oder Wasser
• 2 Lorbeerblätter
• 1 kleine Handvoll Korianderstiele (Blättchen zum Servieren aufbewahren)
• 160 g getrocknete Aprikosen, halbiert
• 1 TL Kreuzkümmel, gemahlen
• Knoblauch-KräuterLabneh (siehe oben)
• Grüne Sauce (siehe oben)
Für das Tabil in einer kleinen Schüssel Koriander, Kurkuma, Kümmel und Pfeffer vermischen. Am Tag vor der geplanten
Zubereitung die Hühnerteile auf beiden Seiten großzügig mit koscherem Salz würzen. In einer mittelgroßen Schüssel die Harissapaste mit etwa der Hälfte des Tabil verrühren. Die Hühnerschenkel hineingeben und von Hand gleichmäßig mit der Mischung einreiben. Zudecken und über Nacht in den Kühlschrank stellen. Vor dem Kochen Zimmertemperatur annehmen lassen.
Einen Rost auf der Mittelschiene in den Ofen schieben und diesen auf 190 °C vorheizen. Eine große, säurebeständige Pfanne bei mittlerer bis hoher Temperatur erhitzen und das Kardamom-Ghee hineingeben. Sobald das Fett heiß genug ist, Zwiebeln, Karotten und Knoblauch hinzufügen. Leicht salzen und das übrige Tabil einstreuen, dann die Temperatur auf mittlere Hitze reduzieren und unter gelegentlichem Rühren ca. 12 Minuten anschwitzen, bis die Zwiebeln weich und glasig sind und anfangen, Farbe anzunehmen. Die Tomaten und den Hühnerfond zugeben und umrühren, sodass alles gut bedeckt ist, dann die Mischung aufkochen lassen. Gemüse-Tomaten-Mischung in einen Bräter (ca. 20 × 30 Zentimeter) füllen und Lorbeerblätter sowie Korianderstiele hineinlegen. Die Hühnerschenkel mit der Hautseite nach unten auf die Aromaten betten, dann die Aprikosen um die Hühnchenteile verteilen. Diese sollten etwa halbhoch in der Schmorflüssigkeit liegen, bei Bedarf einen Schuss Wasser oder Brühe angießen. Das Huhn mit Pergamentpapier abdecken und die Form fest in Alufolie einpacken.
Ungefähr 1 1/2 Stunden im Ofen garen, bis die Hühnerschenkel komplett durch sind und das Fleisch beim Anstechen mit einem scharfen Messer keinerlei Widerstand mehr spüren lässt. Sobald das Huhn ganz durch ist, den Ofenrost auf der obersten Schiene einschieben und die Temperatur auf 220 °C erhöhen. Folie und Pergamentpapier vom Bräter entfernen und die Hühnerschenkel wenden, sodass die Hautseite jetzt nach oben zeigt. Den Kreuzkümmel in die Schmorflüssigkeit einrühren. Den Bräter zurück in den Ofen stellen und das Huhn 18 bis 20 Minuten schmoren, bis die Flüssigkeit schön eingekocht und die Hühnchenhaut knusprig und goldbraun ist. Zum Servieren die Hühnerschenkel mit einer Küchenzange vorsichtig herausholen und auf einem Servierteller mit hohem Rand oder in einer flachen Schüssel anrichten. Lorbeerblätter und Korianderstiele entfernen. Die Schmorflüssigkeit probieren und nach Geschmack mit Salz nachwürzen, dann die Aprikosen und den Bratensaft über die Hühnerschenkel verteilen. Mit Korianderblättern bestreuen und mit gedämpftem Couscous, Knoblauch-Kräuter-Labneh und Grüner Sauce servieren. Reste von Fleisch, Aprikosen und Bratensaft halten sich in einem verschlossenen Behälter im Kühlschrank bis zu einer Woche, im Gefrierschrank bis zu drei Monaten. Vor dem Servieren kurz aufkochen lassen.
Für eine Lamm-Tajine das Huhn durch 2 Kilo Lammschulter ohne Knochen, in ca. 7 bis 8 Zentimeter große Stücke geschnitten und im Voraus gesalzen, ersetzen. Vor dem Anschwitzen der Aromaten 3 Esslöffel Ghee (siehe Seite 62) oder Öl in einem Schmortopf bei mittlerer bis hoher Temperatur erhitzen. Das Lamm von allen Seiten anbraten, ca. 4 Minuten pro Seite, dann das Fleisch herausnehmen und zur Seite stellen. Das verwendete Fett abgießen, dann wie im Rezept beschrieben fortfahren und die Aromaten in frischem Ghee anschwitzen. Das Lamm wird vermutlich bis zu 30 Minuten länger brauchen als das Huhn, um zart zu werden.










































Mit der Deutschen Umwelthilfe haben wir Klimaschutz als Grundrecht durchgesetzt.
Jetzt bringen wir gemeinsam die Bundesregierung dazu, es auch umzusetzen.






















Mach es wie Aurelia, Hauke & Miriam. Mach mit. Für uns alle. www.duh.de/50jahre











































FÜR JUNGES DESIGN 6.+7. DEZEMBER MARX HALLE
FOOD FASHION SHOPPING LIFESTYLE


















SchreibtischOrganizer Für-immerBlumenstrauß










Gesamtes Sortiment unter: werkhaus.de/shop
WERKHAUS Design + Produktion GmbH | Industriestr. 11 + 13 | 29389 Bad Bodenteich

Aufbewahrungskörbe stapelbar































Schenken ist schwierig – jedes Jahr aufs Neue. Wir versuchen es trotzdem.

URSEL NENDZIG
Wahnsinn, was Teenager essen! Mit diesem Kochbuch können sie die Unmengen, die sie verschlingen, zumindest selber herstellen. »Echt gut kochen« für hungrige TeenagerInnen ab zehn Jahren, bestellbar bei der Buchhandlung ums Eck. dorlingkindersley.de
Alles besser als Blockflöte! Auf dieser lässigen Ukulele von Fender können kleine und große Kinder mit wenig Übung gleich die Weihnachtslieder begleiten. fender.com



Kerzenreste werden ab jetzt nicht weggeworfen, sondern ganz einfach verfüttert: an diesen Dauerbrenner mit ewigem Docht Manufaktur.
MARTIN MÜHL

Familienkonstellationen sind dynamisch, da muss die Einrichtung mitspielen, wenn man für Kinder, sich oder Gäste einen Schlafplatz organisieren will, ohne dauerhaft viel Platz zu beanspruchen. Das Bett 2.0 von »Room in a Box« ist komplett aus Wellpappe, lässt sich in verschiedenen Größen »aufstellen« und jederzeit zusammenschieben und so platzsparend verstauen. Und am Ende seiner Lebenszeit wird es zur begehrten Ressour-



Die (Geld-)Börse bleibt ein gutes Geschenk, ohne viel Fragerei lässt sich im Alltag feststellen, ob die oder der zu Beschenkende möglicherweise eine neue brauchen kann und in welcher Farbe. Umso besser, wenn die nicht zur Rentabilität von umweltzerstörerischer Massentierhaltung beiträgt und durch toxische Chemikalien im Gerbeprozess noch einmal Natur und Menschen vergiftet. Zum Beispiel bei der mit deutschem Bioleder in Deutschland fertigenden Manufaktur Thann – eine persönliche Prägung von maximal 7 Zeichen kann gleich online mitbeuaftragt werden. Neben der Geldbörse gibt’s weitere dezent gebrandete Lederwaren wie den Gürtel »Vils-35« in der Farbe »Bienenwachs«. thannleder.de
Auch wer bei Bürsten auf Kunststoff verzichten will, landet aufgrund von Langlebigkeit und Pflegeeigenschaften unter den Naturborsten oft bei tierischen Materialien. So auch bei Haarbürsten, nämlich denen vom Schwein, in mehrerer Hinsicht besser: denen des Wildschweins. Um der armen Schweine und der eigenen Kopfhaut willen sollte auch hier auf Qualitäts- und Ethikstandards Wert gelegt werden. Für deren Transparenz und Einhaltung garantiert im Falle von »Noelie« (das die Wildschweinborsten aus Spanien bezieht) der Naturkosmetikstandard Cosmos. Im Bild sind die Borsten in einer Bürste aus Nussholz verarbeitet.
noelie.de




Der Autowahn bleibt ungebrochen, der Individualverkehr geht als großes Freiheitsversprechen in die nächste Generation: Auf Kindergeburtstagen werden Autos in Miniatur verschenkt. In Kinderbüchern knattern –Brumm! Brumm! – lautstark die Verbrennungsmotoren. Was wir der Ersatzreligion Automobil entgegensetzen können: schöne Kleidung für die Kleinen, die attraktive Alternativen aufzeigt, zum Beispiel die Shirts, Röcke und Hoodies mit den traditionellen Straßenbahnmotiven von Soova aus Wien. Die modischen Statements des kleinen Familienunternehmens (das einen Shop in Wien-Neubau betreibt) sind auch
für Erwachsene erhältlich. Das Design wird mittlerweile auch von den Wiener Linien in deren Fanshop verkauft.
soova.at
Hintergründigeres zur Geschichte des öffentlichen Verkehrs lässt sich auch nachlesen, zum Beispiel im »Wiener Öffi-Wörterbuch« (Ueberreuter, 2025) von Erich Kocina. Erklärt wird, was »Amerikaner« waren (42 gebrauchte Straßenbahngarnituren aus New York City, die in den 1950er-Jahren aus Mitteln des Marshallplans gekauft wurden und bis 1969 durch Wien kurvten) oder wann Schaffner von den Wiener Verkehrsbetrieben wegrationalisiert wurden (1964–1996). ueberreuter.at
Ältere Alben von Wolfgang Ambros eignen sich übrigens auch gut als Geschenk, zum Beispiel »Schaffnerlos« (1978) als Langspielplatte.
19/11/25
Mi, 19.30 Uhr · Großer Saal
Lesung und Gespräch in englischer Sprache
»No way home«
Ben Becker
Lesung in deutscher Sprache
Katja Gasser
Gespräch, Moderation
In Kooperation mit ShowConnection

Empfehlungen, Warnungen, warnende Empfehlungen. Von Neuentdeckungen und alten Perlen. Auf dass uns Weghören und -sehen vergeht.
BETTINA UND CHRISTIAN KUTSCHENREITER / »GESTATTEN: BIBER« / Ludwig, 2024.

Nachgelesen für alle, die an den Erkenntnissen aus der ungewöhnlichen Freundschaft mit einer wilden Biberfamilie teilhaben wollen.
MAX FRISCH / »FRAGEBOGEN« / Suhrkamp, 2019.
Nachgelesen für alle, die Anregungen suchen, im Alltag über existentielle Fragen zu philosophieren.
GUNNAR LANDSGESELL
Wer weiß, dass Biber, sobald Junge im Bau sind, Holzschnitzel wie Einstreu produzieren, um den Unrat der nicht stubenreinen kleinen Biber alle zwei, drei Tage nach draußen zu befördern? Oder: dass Biber Eicheln fressen, wenn die Grundbesitzer die gefällten Bäume samt Ästen und Blättern entfernt haben? Und wer weiß, dass Rehe oder andere Wildtiere im Fall der Anwesenheit von Menschen sich an Bibern orientieren, um zu entscheiden, ob sie bleiben oder sich lieber verziehen? Dinge wie diese sind im Buch von Bettina und Christian Kutschenreiter zu lesen. Sie arbeitet als technische Zeichnerin, er als Elektroingenieur. Das Besondere daran: Die Erkenntnisse wurden durch die jahrelange Freundschaft mit einer wilden Biberfamilie zusammengetragen. Damit ist »Gestatten: Biber« kein wissenschaftliches Buch, aber auch keine Verklärung. Wer sich für diese Tiere interessiert und noch nicht viel weiß, kann im Stil des Nature Writing einiges erfahren. Ganz ohne lästige Mückenschwärme, denen die NaturfotografInnen sich aussetzen, werden einige Mythen geklärt und neue Einblicke gewährt.
Eine der besten Fragen ist gleich die allererste: »Sind Sie sicher, dass Sie die Erhaltung des Menschengeschlechts, wenn Sie und alle Ihre Bekannten nicht mehr sind, wirklich interessiert?« Die Zweite legt nach: »Warum? Stichworte genügen.« Das klingt – /Stichworte genügen/ – allzu einfach. Doch nur wenige der Fragen, die Max Frisch in seinen Fragebogen gepackt hat, lassen sich leicht beantworten. Fast immer tut sich ein Universum auf, in dem wir unsere Gedankenwelt ergründen müssen. Ihr Autor selbst bezeichnete seine Aufgabenstellungen in einem Interview einmal als »hinterhältige Fragen. Fragen, die ich nicht beantworten könnte«. Max Frisch (1911–1991) war – neben Friedrich Dürrenmatt – der bekannteste Schweizer Schriftsteller seiner Generation. Einige seiner Werke haben es in den Kanon geschafft; die Romane »Homo faber« und »Stiller«. Auch Stücke wie »Andorra« oder »Biedermann und die Brandstifter« werden immer noch gespielt. Am populärsten aber ist sein »Fragebogen«, der eigentlich eine Reihe von Fragebögen umfasst. Der Suhrkamp Verlag pflegt das Werk seines Autors und hat 2019 eine um drei »neue«
Fragebögen erweitert (das heißt: um einen wenig bekannten und zwei bis dahin unveröffentlichte). Sie widmen sich jeweils einem Themenkomplex: Moral, Alkohol, Technik. Während die Fragen zu Suff und Gewohnheitstrinken in ihrer Maßlosigkeit aus der Zeit gefallen wirken (»Gesetzt den Fall, Sie hätten jemand auf der Straße überfahren: würden Sie den Umstand, dass Sie unter Alkohol gewesen sind, als mildernden Umstand gelten lassen?«, »Möchten Sie unter Alkohol sterben?«), sind jene zur Technik in ihrer Grundtendenz eher zeitlos (»Können Sie sich denken, dass der menschliche Geist, den wir schulen, im Grund auf Selbstvernichtung der Spezies angelegt ist?«). Fordernde Lektüre. Als leichtes Gepäck – weil als Büchlein klein und kompakt – trotzdem ideal für Rucksackreisen oder tiefsinnige Gespräche auf längeren Autofahrten.
ROBERTO GROSSI / »DIE GROSSE VERDRÄNGUNG« / Avant, 2024.

THOMAS WEBER
Nachgelesen für alle, die einen Abriss über den Klimawandel und seine biologischen wie sozialen Zusammenhänge in gelungenen Panels zu schätzen wissen.
Roberto Grossi lebt in Rom und arbeitet als Architekt, Illustrator und Comic-Autor. Sein aktuelles Buch »Die große Verdrängung« widmet er dem Klimawandel und dessen Zusammenhängen mit Kapitalismus, Industrialisierung und sozialen Auswirkungen. In der Beschreibung kom -
plexer ökologischer Zusammenhänge geht er nicht in die Tiefe der Details, formuliert aber so treffsicher, dass seine Aussagen in ihrer Klarheit beinahe banal anmuten. Er bringt die nicht zum ersten Mal formulierten Fakten und Verbindungen aus antikapitalistischer Sichtweise in wenigen Worten auf den Punkt. Was sein Buch aber noch mehr von einem Gros der Veröffentlichungen abhebt, sind seine Zeichnungen und das Setzen der Panels (also der Bildrahmen im Comic). Er schreckt nicht vor drastischen Bildern von Krieg und Umweltzerstörung zurück, sucht aber auch keine gespielte Dramatik. Und immer wieder machen erst der Bildausschnitt und die Komposition die ganze Dringlichkeit und Wucht aus. Der Inhalt ist traurig und hart – die Machart des Buches ein Lehrbeispiel für Storytelling durch Zeichnungen und Bildausschnitte. Gemeint ist »Die große Verdrängung« als Appell, nicht wegzusehen, sondern aktiv zu werden.
SARA FROMM / »ZUVERSICHT JETZT« / Löwenzahn, 2024.

MARTIN MÜHL
Nachgelesen für alle, die Ratschläge suchen, wie sich »den Krisen der Welt mutig begegnen« lässt.
Schon bald fällt auf, dass dieses Buch nicht nur ein strategischer Reader ist, wie man mobilisiert und Kampagnen akribisch plant, sondern dass dahinter eine Autorin steht, die aus offenkundiger Überzeugung handelt bzw. hier schreibt. Umwelt-, Klima- und soziale Themen (das lässt sich selten tren-
nen) etwa einer Politik entgegenzustellen, die interessensversessen, aber zukunftsvergessen agiert. Allesamt Themen, für die es sich zu kämpfen lohnt – selbstverständlich gewaltfrei, wie sie mit einem Zitat von Jürgen Habermas ausführt. Die Kapitel spielen grundlegende Fragen durch: Ist individuelles oder kollektives Handeln gefragt? Welche Strategien versprechen »Erfolg«? Wie legt man es an, ohne selbst auf der Strecke zu bleiben? Und will man mit dem Kontrahenten am Ende ins Gespräch kommen oder was soll am Ende eines Prozesses stehen? Die Orientierung an positiven, also erfolgreichen Kampagnen spielt dabei eine wichtige Rolle. Sara Fromm hat ihr Buch so umsichtig angelegt, wie es wohl auch ihr Anspruch an die Planung von Kampagnen ist. Die Sprache ist klar und umsichtig, die Trainerin und Moderatorin bringt offenkundig viel Erfahrung und theoretisches Wissen ein.
GUNNAR LANDSGESELL
/ DVA, 2022.

Nachgelesen für Männer, junge Frauen und alle, die über Regelarbeitszeit nachdenken.
Schrecklicher Titel, gutes Buch: Wer sich von »Kümmerfalle« angesprochen fühlt, gehört womöglich entweder zu jenen, die sich kümmern und ohnehin für quasi alle Eventualitäten vorsorgen, oder jenen, die schon in der Kümmerfalle sitzen – und somit in beiden Fällen nicht zu denen, für die die Lektüre am dringendsten wäre: erstens alle, die (noch) verhältnismäßig wenig Reproduktionsarbeit geleistet haben (keine Kinder, keine nennenswerte Hausarbeit für andere als sich selbst, keine Pflegeverantwortung) – oft
sind das Männer. Zweitens alle, die sich als Teil einer Gesellschaft wähnen, die Erwerbstätige grundsätzlich durch Phasen der Unterbrechung oder Reduktion der Lohnarbeit zugunsten von Care-Arbeit durchträgt, und so vor finanziellem Absturz, zumindest aber vor Armut schützt. Doch das tut sie freilich nicht. Viele Menschen sind nach wie vor nur durch eine Partnerschaft vor einem Leben in Armut geschützt – ein klassisches Abhängigkeitsverhältnis, dessen rechtliche Details und mitunter daraus resultierende praktische Bosheiten – von Staat zu Staat variieren. Über die Gründe dieser systemischen Aufrechterhaltung der Abhängigkeit von nicht zufällig meist Frauen wird im Buch mit den üblichen (mehr als plausiblen) Überlegungen gemutmaßt, wichtiger aber: Es wird wieder einmal recht klar veranschaulicht, wie unbezahlte Reproduktionsarbeit, Altersarmut von Frauen, Familienleben unter Druck für alle ihre Mitglieder, Ehe- oder PartnerInnenschaftsrecht, Pflegenotstand und die moderne (unrealistische) Vorstellung einer typischen menschlichen Erwerbsbiografie zwangsläufig zusammenhängen. Die AutorInnen der »Alles-ist-möglich-Lüge« (2014) zur Vereinbarkeit von Beruf und Familie sind keine Wissenschaftlerinnen, sondern vor allem Reporterinnen/Redakteurinnen, die beide unter anderem Politologie studiert haben, vor allem aber spürbar aus geballter eigener und gezielt von anderen gesammelter Lebenserfahrung sprechen. So gelingt es ihnen, die Wechselwirkungen zwischen den unterschiedlich privaten und öffentlichen Sphären, Entscheidungen und Regelungen, die in Summe über die Möglichkeit eines selbstbestimmten Lebens trotz Übernahme von Care-Verantwortung entscheiden, darzustellen. »Damit nicht jede Generation immer wieder von vorne anfangen muss«, schreiben die AutorInnen, und liefern einen relevanten und leider vermutlich noch längere Zeit auch in den Details aktuellen Beitrag zur Diskussion um Teilzeitarbeit, Regelarbeitszeit, bedingungsloses Grundeinkommen und emanzipatorische Gleichstellung. Vor allem das letzte Drittel des Buches widmet sich dem Nachdenken über Care-Arbeit in alternativen Wirtschaftsmodellen: Ist die »Monetarisierung aller Lebensbereiche« brutal – oder ist es brutaler, einen Teil der Arbeit von ihr auszuschließen in einer Welt, in der Arbeit erst durch Lohn realisiert wird? Kümmern oder Fürsorgearbeit sind schönere Wörter als Reproduktionsarbeit, aber sie suggerieren eben auch, dass die ganze Arbeit aus Fürsorglichkeit als Charaktereigenschaft lieber gemacht wird – was, selbst wenn, aber weitestgehend unerheblich ist, da sie im Sinne aller in der Familie und prinzipiell auch in der Gesellschaft nun einmal gemacht werden muss.
Ein Fest dem Naturwein.
Am 7. und 8. November findet in Strass im Kamptal die erste »Natural Kamptal« statt – BIORAMA ist stolzer Medien- und Programmpartner. Geboten wird unter anderem die Möglichkeit, 120 Weine von 17 WinzerInnen aus der Region (großteils Bio) und von über 20 Rebsorten zu verkosten. Abgerundet wird der Event durch Podiumsdiskussionen, ein WinzerInnen-Dinner und jazzigen Ausklang. natural-kamptal.at

• Bio Küche



Jährlich sechs Ausgaben direkt in deinen Briefkasten!
Auch wenn BIORAMA ein Gratismagazin ist, kannst du es abonnieren und bekommst jedeAusgabe nach Hause geschickt – bei einem Wohnsitz in Österreich auch unsere Line-Extension BIORAMA Niederösterreich. Für 25 EUR im Jahr bist du dabei und unterstützt unsere unabhängige redaktionelle Arbeit.
biorama.eu/abo


BIORAMA BIOKÜCHE 2026


Das BIORAMA-Bookazine für alle ÖsterreicherInnen, die Wert auf biologische Küche legen, geht in die sechste Runde! Wir zeigen die Vorzeigebetriebe der Bioverpflegung genauso wie jene, die deren Grundlagenarbeit machen: BioproduzentInnen von Vorarlberg bis zum Neusiedler See. Bei uns erzählen sie, worauf sie stolz sind und womit sie hadern. Dieses Jahr zum Schwerpunkt Fiber – denn Ballaststoffe sind fast überall in unserer Nahrung und trotzdem bekommen wir oft nicht genug davon. Richtig viele, richtig gute Produktempfehlungen, ernährungsphysiologisches Wissen, Küchentipps und Rezepte gibt’s wie immer obendrauf! Die nächste Ausgabe erscheint Ende 2025. Die bisherigen Ausgaben der BIORAMA BIOKÜCHE sind auch online. biorama.eu/ausgaben
TEXT
Ursel Nendzig
Manchmal braucht es einen Stunt, um nicht zu bekommen, was das Kind möchte.

BAutorin Ursel Nendzig, Mutter zweier Söhne, berichtet live aus der Achterbahn.
eide Söhne haben prachtvolle, lange Mähnen. Damit war nicht von Anfang an zu rechnen. Allein schon, weil der große Sohn sich bis zum zweiten Geburtstag nur sehr widerwillig kaum sichtbare, mehr an Entenkükenfedern denn an menschliches Haupthaar erinnernde Fusseln wachsen ließ, bevor das Ganze endlich in Fahrt kam. Im Gegensatz dazu verlief der Haarwuchs des zweiten Sohnes von Anfang an bilderbuchhaft, durchschnittliche Behaarung bei der Geburt, guter Schopf mit einem Jahr, keine Beanstandungen. Sein Haar fällt heute in kräftigen Strähnen bis über die Schultern. Es wird mit ausgewählten Bürsten aus der beachtlichen Haarbürstensammlung täglich zum Glänzen gebracht, mit Haarkuren verwöhnt und beim Sport mit einem Haarband aus der Stirn und in Szene gebracht. Immer wieder musste er sich dafür dumme Kommentare anhören, sogar innerhalb der Großfamilie, warum er denn eine »Mädchenfrisur« trage. Ich weiß bei solchen Sagern immer nicht so ganz, wo ich anfangen soll und vor allem, ob ich jemals wieder aufhören könnte. Ich kann nur sagen: Ich feiere die langen Mähnen der Söhne extrem. Ich liebe alles daran. Umso erschütterter war ich, als der kleine Sohn verkündete, er wolle jetzt eine Kurzhaarfrisur. Zur Veranschaulichung zeigte er mir ein paar Bilder online, die mich in blankes Entsetzen versetzten. Es waren durch die Bank Bilder von Sportlern und »Celebritys« zweifelhafter Genres, allesamt sehr gutaussehend und mit einer fabelhaften »Jawline« ausgestattet –ein Statussymbol unter jungen Männern, offensichtlich. Seitlich
akkurat kurz, oben wuschelig: So eine Frisur wünsche er sich auch. Nun setzte ich zu einem Stunt an, den ich die »wundersame Wunschumkehr« nenne. Das Prozedere ist heikel, aber wenn es funktioniert, schlicht genial und geht so: Man versucht, so gut es geht, aus dem Selbst zu entschlüpfen, sich völlig abzukapseln von allem, was man fühlt, denkt, will. Das ist ein wichtiger Schritt, ohne den es schwierig wird. Dann antwortet man auf den Wunsch des Kindes, ohne zu zögern, mit: »Ja, klar!« Idealerweise ist man so sehr von sich selbst losgelöst, dass man sogar noch einen nächsten Schritt
»Nun ist es an der Zeit, in die eigene Identität zurückzukehren und die wundersame Wunschumkehr zu genießen.«
vorschlagen kann, in meinem Fall: »Ich mach gleich morgen einen Termin bei der Frisörin aus.« Und nun kommt es zum Wundersamen: Das Kind ist so perplex, dass es seinen eigenen Wunsch zu hinterfragen beginnt, allein, weil es ihm suspekt vorkommt, mit dem Elternteil einer Meinung zu sein. Nun ist es an der Zeit, wieder in die eigene Identität zurückzukehren und die wundersame Wunschumkehr zu genießen. Mit allergrößter Wahrscheinlichkeit sagt das Kind nämlich so etwas wie: »Was, morgen schon? Ich dachte, irgendwann.« Und langsam, aber sicher, versickert der Wunsch, wie Haare im Abfluss. Heißt: Obacht! Sie könnten sich unter der Oberfläche verheddert haben und jederzeit wieder auftauchen.

Österreichs Streamingplattform Jetzt entdecken
Aufwachsen zwischen 1938 und 1955

